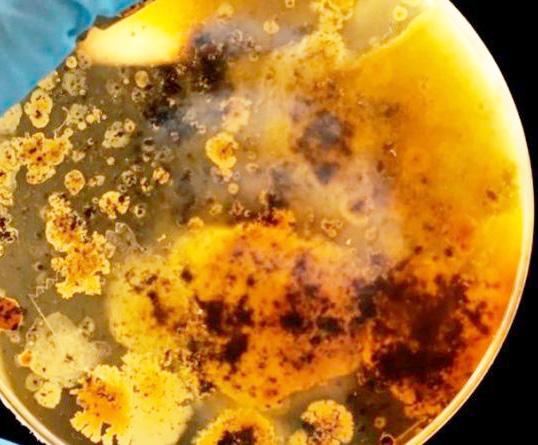

MARTES 22 DE NOVIEMBRE DEL 2022 · AÑO 11 · Nº. 4163 · 32 PÁGINAS · VALOR $7.00 WWW.SIE7EDECHIAPAS.COM 3 5 7 3 Reconoce Rutilio Escandón a jóvenes por su trabajo, compromiso y amor a Chiapas Mi compromiso es Chiapas: Llaven Abarca Surgen más voces en favor de Adán Augusto, el presidenciable favorito “Lo más importante es reducir el gasto en el INE” Para transformar cultura vial y prevenir accidentes de tránsito, Salud impulsa campaña permanente Entregan aparatos de alta tecnología a Centrales de Equipo y Esterilización de hospitales Terminan en muerte 1 de cada 20 accidentes viales En Chiapas se generan oportunidades de inclusión laboral y productiva En Benemérito de las Américas, mejoramos la calidad de vida de las familias 8 MORENA LÓPEZ OBRADOR DR. PEPE CRUZ RUTILIO ESCANDÓN 27 7 4 25 Faltó el brazalete, rebosaron los goles CATAR 2022 16
El tema del momento sin duda es sobre el mundial de Qatar 2022, pero háblelos un poco de las prohibiciones que ante puso este país conservador. La decisión de realizar un Mundial de fútbol en Qatar no fue fácil; clima, seguridad, prohibiciones, religión, cultura y orientación sexual fueron cosas que se hablaron y que los occiden tales deben de pensar antes de asistir a esta Copa del Mundo. Recordemos que estamos hablando de país pe queño con menos de tres millones de personas de los que un 80 % son extranjeros; además de eso hay que sumarle que es conservador, multicultural, acogedor y seguro. El torneo es, sin duda, uno de los más polémi cos de la historia, tanto por los casos de corrupción en el seno de la FIFA en la elección de la sede como por las condiciones laborales de los trabajadores durante la construcción de los estadios y las infraestructuras, la igualdad entre hombres y mujeres o la censura a la comunidad LGTBI. Se trata de un país con normas culturales y religiosas identitarias. En general, se reco mienda vestir cubriendo los hombros y que los pantalo nes lleguen por debajo de las rodillas, está restringido el consumo del alcohol, no son bien vistas las muestras de afecto entre parejas y es mejor no quedarse mirando a la gente o fotografiarla sin permiso. Escupir en la calle o tirar basura al suelo está sancionado y hay tolerancia cero con las drogas. Como mexicanos al leer esto, nos asusta, puesto que como le hará un mexicano si por naturaleza es ruidoso, alcoholico con todo respeto, y sí que en este tipo de fiestas mundialistas es lo que les alegra. Bueno sumemos a los demás países que también traen la fiesta en la sangre, es difícil pero tam bién tendría que ser imposible porque al no cumplir se estaría hablando de sanciones fuertes, tras no cumplir. Esperamos que puedan cumplir y no exista muchos in cidentes, porque vea que la lista en grande: Todos los visitantes pueden utilizar la ropa de su elección, aun que se pide que las personas cubran los hombros y las rodillas cuando visiten lugares públicos. Los trajes de baño pueden ser usados en playas y albercas. Para las mujeres se solicita evitar el uso de vestidos cortos, bermudas, shorts o playeras con escote. Las demos traciones públicas de afecto están mal vistas en Qatar, y eso aplica a todos, pero más en personas del mismo sexo, por lo que se pide a los aficionados respetar las normas locales. Uso de cámaras No está permitido to
mar fotografías de edificios gubernamentales, además se solicita a los aficionados pedir permiso antes de foto grafiar o filmar a miembros del público en los estadios. Cervezas en los estadios Pese a que primero se había confirmado que se vendería cerveza en los alrededores de los estadios mundialistas, en las últimas horas se dio a conocer que esto no sucederá, por lo que Qatar solo permitirá la venta de alcohol en las ‘fan zones’ y los pun tos con licencia. Otras prohibiciones en Qatar 2022 No se permitirá festejar en la calle. Tirar basura en la calle podría costar una multa de hasta 50 mil pesos mexica nos. No se podrá acceder a Qatar con libros religiosos o pornografía. Para muchos suena a exageración pero es así la cultura y para ellos es algo mu pero mu normal. Uno de los temas más fuertes a tratar en Qatar es sobre la homosexualidad; países como Nigeria, Arabia Sau dita, Afganistán, Emiratos Árabes Unidos y Sudán son algunos de los que si hay una pena de muerte contra los homosexuales. En cuanto a Qatar, aunque no penaliza a los gays, si la castiga y podrían ser condenados a sie7e años de cárcel si tienen relaciones con otra per sona de su mismo sexo. La FIFA ya tenía conocimiento sobre el lugar donde se festejaría el evento más grande del soccer, sabiendo que sería una apuesta arriesgada para todos aquellos que irían, en especial los aficiona dos homosexuales. Qatar es uno de los setenta países del mundo que consideran delito la orientación sexual, provocando que muchos activistas busquen terminar con estas leyes homofóbicas. Sep Blatter, ex presidente de la FIFA, había dicho que gays y lesbianas que asis tieran a Qatar en esa temporada se abstengan de toda actividad sexual. Este comentario generó indignación de las diferentes asociaciones internacionales de la comu nidad LGBT+, ya que sienten que en vez de apoyarlos se ha aliado con los represores. A pesar de que la FIFA mencionó que el país de Medio Oriente iba a ser toleran te, algunos mencionaron que los hoteles establecidos les están negando hospedarse o les dicen que se comporten e insisten en que su vestimenta no “fuera gay”. Ante la negativa de los hoteles al no dejar rentar una habitación a personas de la comunidad LGBT+, la FIFA lanzó un comunicado en donde señaló que “se asegurará de que los hoteles mencionados vuelvan a ser conscientes de los estrictos requisitos en relación con la recepción de huéspedes de manera no discriminatoria”.




EL COCO DE TODAS LAS VOCES
es uno de los 70 países en el mundo donde están criminaliza das las relaciones sexuales
Editorial
Directorio General FRANCISCO GRAJALES PALACIOS Presidente del Consejo. (direccion@sie7edechiapas.com.mx) GASTÓN IVÁN MÜLLER Director General. (director@sie7edechiapas.com.mx) CRISTINA GRAJALES CARRILLO Editor Responsable. (redaccion@sie7edechiapas.com.mx) CLARIBEL GRAJALES CARRILLO Representante Legal. (legal@sie7edechiapas.com.mx) El Sie7e es impreso y distribuido por El Sie7e de Chiapas de S.A de CV. Numero de Certificado de Reserva otorgado por el instituto Nacional de Derechos de Autor: 04-2021-092016494100-101. Número de Certificado de Licitud de Título y Certificado: 16746. Calle 12 de Octubre, colonia Bienestar Social, entre México y Emiliano Zapata. C.P. 29077. Tuxtla Gutiérrez, Chiapas. Tel: 01 961 12 137 21 direccion@sie7edechiapas.com.mx Los firmantes son responsables de sus articulos. Martes 22 de noviembre del 2022 · Año 10 · Nº 4163 Queda prohibida su reproducción parcial o total sin la autorización de esta casa editorial y/o editores.
Qatar
DIPUTADO FEDERAL
Mi compromiso es Chiapas: Llaven Abarca



 COMUNICADO - EL SIE7E
COMUNICADO - EL SIE7E
Tuxtla.- En el marco de su pri mer informe de trabajo en la Sexagésima Quinta Legislatura, el diputado federal Jorge Llaven Abarca dio cuenta al pueblo de Chiapas de las actividades que ha llevado a cabo en la Cámara de Diputados para garantizar el bienestar, la salud, la seguri dad, educación y justicia de las y los mexicanos, destacando que continuará trabajando con sentido humano y siempre al lado de gente.
Acompañado por Cecilia Flores Pérez, secretaria de Gobierno, quien acudió en representación del gobernador Rutilio Escandón Cadenas; su esposa y presiden ta del Voluntariado “Siempre al lado de la gente”, Lupita Gómez Casanova; y Adriana Grajales Gómez, secretaria nacional de las Mujeres de Morena; el le gislador suchiapaneco afirmó que hoy la Federación y el Go bierno del Estado trabajan de manera coordinada y en unidad para impulsar programas socia les, iniciativas y estrategias que contribuyan a construir un mejor México.

“El presidente Andrés Manuel López Obrador y el goberna dor Rutilio Escandón Cadenas impulsan políticas públicas en focadas en garantizar salud, seguridad, justicia y bienestar de las y los mexicanos; mi com promiso es Chiapas y desde la Cámara de Diputados defende ré y levantaré la voz para que a nuestro estado le vaya bien, beneficiando y priorizando a grupos en situación de vulnera bilidad”, declaró.
En este marco, destacó que ha participado y respaldo iniciati vas que contribuyan a fortalecer y promover la democracia parti cipativa a través de la Reforma Electoral y la Revocación de
Mandato, así como a defender el patrimonio de las y los mexi canos, como es el caso del litio con las Reformas a la Ley Mi nera; así como en propuestas para combatir la corrupción, ha cer justicia social, así como en materia de inclusión e igualdad de oportunidades, y seguridad pública.
“Vamos a seguir sumando es fuerzos para atender las de mandas de todos los sectores de la sociedad, vamos a con tinuar respondiendo a la con fianza de las y los chiapanecos, vamos avanzando en la conso lidación de la Cuarta Transfor mación, junto con el presidente Andrés Manuel López Obrador y el gobernador Rutilio Escandón Cadenas”, puntualizó.
A este importante evento asistie ron también familiares y amigos del diputado federal, el diputado
federal Roberto Rubio Montejo, delegado nacional del Partido Verde Ecologista de México (PVEM), Valeria Santiago Ba rrientos, presidenta estatal de este instituto político; así como el diputado federal Juan Pablo Montes de Oca; Karen Yaiti Cal cáneo Constantino, secretaria de Finanzas de Morena; Hugo Roblero Gordillo, integrante de la Comisión Ejecutiva Nacional del Partido del Trabajo (PT); las y los coordinadores estatales Kalyanamaya de León Villard, del Partido Encuentro Solidario Chiapas; y Abundio Peregrino García, del Partido del Traba jo; Carlos Morales Vázquez, presidente municipal de Tuxtla Gutiérrez; alcaldes de diferen tes regiones de la entidad; re presentantes de asociaciones y cámaras; medios de comunica ción; entre otros.
Estado
Martes 22 de noviembre del 2022
www.sie7edechiapas.com
DR. PEPE CRUZ

Para transformar cultura vial y prevenir accidentes de tránsito, Salud impulsa campaña permanente
COMUNICADO - EL SIE7E
Tuxtla.- De acuerdo con el Secreta riado Técnico del Consejo Nacional para la Prevención de Accidentes, de enero a noviembre de 2021, Chia pas registro más de 3 mil 400 acci dentes viales en zonas urbanas y su burbanas, por lo que el secretario de Salud del estado, doctor Pepe Cruz, anunció la campaña intensiva deno minada “Dale seguridad a tu vida”, cuya finalidad es que la población extreme medidas de seguridad al conducir el automóvil, cruzar la calle y al usar motocicletas y bicicletas. El doctor Pepe Cruz informó que de los 3 mil 448 accidentes viales regis trados en Chiapas, el 31 por ciento ocurrieron en el primer trimestre de 2021, donde el 86 por ciento de la siniestralidad sucedió en los munici pios de Tuxtla Gutiérrez, Tapachula, Cintalapa, Chiapa de Corzo y Su chiapa, siendo la capital del estado la que presentó un total de mil 729 accidentes.
Expuso que en el horario nocturno fue cuando se dio la mayor ocurren cia, con el 45 por ciento de los acci dentes, seguido del horario vesperti no con el 32 por ciento y el matutino con el 23 por ciento. El grupo de edad más perjudicado es de 15 a 34 años, siendo tres veces más afecta dos hombres que mujeres.
Mientras que por tipo de accidentes, el 46.5 por ciento fueron ocasiona dos por colisión con vehículo auto motor, seguidos por otros tipos de accidentes con el 24.4 por ciento y con el 11.6 por ciento la colisión con motocicleta; en lo que corresponde a accidentes por atropellamiento ocu rrieron 87, de los cuales 63 sufrieron lesiones y 12 fallecieron.
Como parte de la campaña inten siva, el doctor Pepe Cruz hizo las siguientes recomendaciones para evitar accidentes viales: al conducir un automóvil se debe revisar el vehí culo; no manejar si se ingieren bebi das alcohólicas o medicamentos que afecten el estado de alerta, tampoco
CONAGUA
cuando se esté cansado; no usar el teléfono celular para llamadas o textos; colocarse el cinturón de se guridad, tanto el conductor como acompañantes; en caso de que su ban bebés o menores de tres años, utilizar sillas para carro; y respetar los límites y señales de tránsito.
En el caso de los peatones, se les recomienda que cuando crucen las calles, avenidas y libramientos lo ha gan en las esquinas y volteen hacia ambos sentidos de circulación; no abordar ni descender de vehículos en movimiento; si llevan menores o adultos mayores, agarrarlos bien de las manos y evitar que crucen solos las calles.
Mientras que los motociclistas y ci clistas deben utilizar cascos con cer tificaciones adecuadas para mayor seguridad, deben usar el equipo de seguridad, conducir a una velocidad adecuada, mantenerse alerta, man tener su vehículo o motocicleta en buenas condiciones, y conducir con seguridad y responsabilidad.
Frío y lluvias, prevalecerán toda la semana
COMUNICADO - EL SIE7E
Tuxtla.- Los reportes de la Comisión Na cional del Agua en el comienzo de la se mana, dan a conocer que, el frente frío Número 10 y la masa de aire frío asociado a dicho sistema, están debilitándose du rante el periodo de pronóstico, junto con la presencia de bajas presiones sobre el Pacifico sur mexicano, lo que extenderá las bajas temperaturas y lluvias hasta el día viernes.
Derivado de esta situación, podrían de sarrollarse nublados con potencial para intervalos de chubascos con puntuales fuertes en la entidad
En el pronóstico general se expone que, los valores de temperatura máxima, pre sentarán ligeras variaciones por lo que se percibirá un ambiente cálido a ligeramen te caluroso en gran parte de la región, así como muy caluroso en Guerrero y zonas costeras de Chiapas y Oaxaca.
Por la noche, se prevé un ambiente frio a muy frío en zonas serranas.
Para el martes, junto con la masa de aire frío asociado a dicho sistema estarán debilitando; a pesar de tal situación, aún pueden generarse lluvias muy fuertes en Chiapas y Tabasco, así como viento de Norte con rachas de superiores a los 50 km/h sombre el golfo e Istmo de Tehuan tepec.
El ambiente podría percibirse cálido a li geramente caluroso en gran parte de la región, así como muy caluroso en Gue
rrero y costas de Oaxaca y Chiapas. Para el miércoles continuará debilitándo se junto con su masa de aire frío, por tal situación, podrían presentarse intervalos de chubascosos con puntuales fuertes.
El viento continuará de componente Nor te, pero con menor intensidad que días anteriores sobre el golfo e Istmo de Te huantepec.
El jueves, el frente frío número 10 se en contrará estacionario y seguirá debilitán dose, sin embargo, bajas presiones sobre el Pacífico sur mexicano mantendrán las condiciones necesarias para lluvias fuer tes en Oaxaca e intervalos de chubascos en Tabasco y Chiapas. Un nuevo frente frío se encontrará sobre el norte del país.
El viernes, de acuerdo al pronóstico nacional, el nuevo frente frío recorre rá el noreste, oriente y gradualmente el sureste del país, incrementando el po tencial de lluvias puntuales intensas en Veracruz (sur), Oaxaca (oriente), Chia pas y Tabasco.
JAVIER JIMÉNEZ JIMÉNEZ
Prioridad,
acercar
los servicios hacendarios
COMUNICADO - EL SIE7E
Tuxtla .- En entrevista, el secretario de Hacienda, Javier Jiménez Jimé nez, informó que se han instalado 23 módulos temporales en diversos puntos del estado, los cuales tienen el objetivo de acercar los servicios que ofrece la dependencia, y sobre todo, para que las y los propietarios de vehículos y motocicletas, sigan disfrutando de los beneficios fiscales que ofrece el Gobierno del Estado.

La mayoría de es tos módulos se han instalado en coordi nación con los Ayun tamientos, para ofre cer estos servicios a sus habitantes, entre los que destacan el cambio o reposición de licencias, y los más solicitados, los descuentos vigentes para automovilistas y motocicletas.
“Reconozco el traba jo que han realizado las y los servidores públicos pertene cientes a las dele gaciones hacenda rias y los Centros de

Recaudación Local, al colocar estos módulos los sábados y domingos, de esta forma damos mayores facilida des y oportunidades a la población”, subrayó Jiménez Jiménez.
Entre los municipios donde se han instalados los módulos temporales son: Tapachula, Huixtla, Ocosin go, Reforma, San Cristóbal de Las Casas, Comitán de Domínguez, Pa lenque, Villaflores, Zinacantán, La Libertad, Sitalá, Amatán, Ostuacán, Jitotol, La Grandeza y Tzimol.
22 DE NOVIEMBRE DE 2022 SIE7E DE CHIAPAS 4
ESTATAL
4
Terminan en muerte
1 de cada 20 accidentes viales
ALEJANDRA OROZCO - EL SIE7E
Tuxtla.- De acuerdo con la Co misión Nacional para la Preven ción de Accidentes (Conapra), los accidentes de tránsito son la primera causa de muerte en México entre los 5 y 35 años, la segunda causa de discapacidad y también de orfandad… son ya un problema de salud pública, pues se reportan 20 mil muertes y 750 mil hospitalizaciones al año por esta razón.

Este 20 de noviembre se con memoró el día internacional para recordar a las víctimas de este tipo de incidentes, y pre cisamente para reducir estas cifras, un grupo de voluntarios formó un comité preventivo en
la entidad, donde cada integran te desde su trinchera y desde lo que sabe hacer, abone a reducir los índices de mortalidad hasta en un 50 por ciento, como dicta la ONU y la OMS.
“Convoco a taxistas, convoco a la sociedad, convoco a quien
IGLESIAS CRISTIANAS
quiera unirse a esta causa, que en mi caso me ha dejado una pérdida irreparable… en me moria de José Carlos les pido nos unamos a esta causa”, señaló Carlos Fabre, uno de los precursores de esta inicia tiva quien apenas hace unas
Iniciativa de ley atenta contra libertad de expresión de iglesias
RUBÉN
PÉREZ
- EL SIE7E

Tuxtla.- Josué Pérez Pardo, pas tor de la Iglesia Cristiana “Jesús es el Camino”, expuso que las iglesias mexicanas están preocu padas ante una iniciativa que im pulsa un diputado federal entor no a la prohibición de hablar en los cultos u otros espacios sobre homosexualidad y lesbianismo, “porque lo considera como dis curso de odio”.
A pesar de que la Iglesia siempre ha su cumbido a situaciones difíciles de per secución, en todos los tiempos, refirió que todo se agravó durante la pandemia pues, más que vivir entre una enferme dad, se “palpó” un ataque a la fe. Recordó que por órdenes de gobierno y por cuestiones de salud tuvieron que can celar los cultos y cerrar los templos, “lo que nos da una idea de lo que enfrentare mos próximamente”.
El también director nacional de la mis ma organización religiosa, que aglutina a más de 15 mil feligreses en Chiapas y 120 mil en todo el territorio mexicano, destacó que ya no se vivirá una “cacería” porque una persona no copera para una fiesta patronal, sino que ahora ―dijo― se enfrentarán a cuestiones legales, como ya se ve en materias como el aborto o el matrimonio igualitario.
No obstante, mencionó que ahora tratan de cuartar la libertad de hablar acerca de temas relacionados con la homosexuali
dad o el lesbianismo, “el pecado que ha sido una perversidad, como lo que ocurrió en Sodoma y Gomorra”.
Lo que han notado, aceptó, es que este tema será rebasado, es decir que lo más probable es que sea aprobado, “por eso le pediremos a nuestros legisladores en Chiapas, que mantengan a este ser su perior que dicta a nuestros corazones, siempre el camino correcto de la convi vencia y de la paz con Dios y entre noso tros, los hombres”.
Josué Pérez Pardo comentó que ya se comienzan a organizar y apoyarse de abogados para buscar las razones de cómo poder contrarrestar ese tipo de ini ciativas de ley, “no entendemos cómo las minorías han tomado fuerzas en estos te mas, porque es un sistema global”.
Insistió en que este tipo de iniciativas o leyes solo pretenden atacar a la fe, y de alguna manera “vivimos en esos tiempos que la misma Biblia previó, como la des integración familiar”.
semanas perdió a su hijo en un accidente de tránsito en la capital. “En 2021 registramos 88 muertos y mil 100 heridos por esta causa… este 2022 se incrementó en un 30 por cien to con relación al pasado, y lo que te puedo decir es que al día, la Cruz Roja Mexicana atiende de tres hasta cinco ac cidentes que tienen que ver un elemento de tránsito, ya sea auto, moto o peatón”, ahondó Francisco Alvarado Nazar, de legado estatal de la Cruz Roja en la entidad, y es que a ni vel nacional, se reportan dos muertos y 86 heridos por hora en este tenor.
La vía Tuxtla - San Cristóbal, así como los libramientos, son las vías más accidentadas, de
cada 20 accidentes, Nazar con sideró que en uno se pierde la vida por factores como exceso de velocidad, uso de celular -que ocurre en el 50 por ciento de los casos-, así como manejar en estado de ebriedad, este gru po de voluntarios busca reducir estas cifras.
“Es trabajar con los diferentes factores de riesgo que es como el uso de cinturón de seguri dad, a los niños que hagan uso de los sistemas de retención infantil, lo que son las sillitas, y disminuir el uso del celular, la velocidad que es el princi pal factor para que ocurra un hecho de tránsito”, puntualizó Xiomara Ruiz Pascacio, volun taria de seguridad vial de esta iniciativa.
CARAVANA CNTE arriba a la CDMX, busca encuentro con AMLO

CARLOS LUNA - EL SIE7E
Tuxtla.- La Coordinadora Nacional de Trabajadores de la Educación, (CNTE), llegará a la Ciudad de Méxi co, este martes en una caravana que partió desde Chilpancingo Guerrero, para buscar que el presidente Andrés Manuel López Obrador sostenga una mesa de diálogo y cumpla las deman das pendientes del magisterio. Cerca de seis mil maestros y maes tras, partieron el lunes 14 de noviem bre, con rumbo a la capital del país, para pedir que se reinstale la mesa de diálogo que quedó pendiente por la llegada de la pandemia COVID-19, entre la Comisión Nacional Única de Negociación y el gobierno federal. Esta caravana reúne a representacio nes de docentes de Chiapas, Oaxaca, Guerrero, Michoacán, estudiantes nor malistas y organizaciones civiles.
Esperan que, el presidente reciba al contingente y no los reciba con elementos anti motines, como ha ocurrido con otras manifestaciones.
José Luis Escobar Pérez, integran te de la Comisión Ejecutiva de la CNTE dijo que:
“Abrogación total de la ley del SICAMUSICAMM, abrogación de la UMA a jubilados y pensionados, para que nuevamente sean pensionados con base a salarios mínimos y plaza au tomática a todos los egresados de las normales”.
Recordó también que existe un núme ro importante de maestros cesados por las movilizaciones que han reali zado desde el 2013.
En este escenario comentó que: “Las peticiones siguen siendo las mismas, nosotros estamos en la misma pos tura, no dejaremos de levantar la voz para que las demandas sean resueltas lo antes posible, son las demandas del movimiento magisterial y popular”.
Este acercamiento se pospuso en el 2020 y 2021 por el tema de la pande mia Covid-19, pero los docentes es peran que por fin pueda destrabarse el tema.
22 DE NOVIEMBRE DE 2022 SIE7E DE CHIAPAS 5 ESTATAL ACCIDENTES VIALES
Chiapas se mantiene marginado por falta de visión en materia de agroindustria
RUBÉN PÉREZ - EL SIE7E
Tuxtla.- Chiapas, Oaxaca, Ve racruz, Puebla y Guerrero son los estados más marginados del país ancestralmente, a pesar de que hay riqueza pluricultu ral y en su biodiversidad, “pero que no es explotada”, manifestó Francisco Tovar Avendaño, inte grante de la Academia Nacional de Historia y Geografía (ANHG) en esta entidad chiapaneca.
Tras dejar en claro que Porfirio Díaz fue un visionario de las vías férreas, lamentó que no hu biera más avance, por ello, des tacó que es necesario tener una visión más de fondo que articule a los mexicanos para tener una línea comercial de fondo.
Lamentó que quienes han go bernado nuestro país solo doten de tierras a la gente más pobre, pero se carezca, en la actuali dad, de la industrialización del
agro, así como de la transfor mación e implementación de recursos y de programas para que esto coadyuve en un alto crecimiento.
Durante su ponencia en la pre sentación del nuevo presidente de la ANHG en Chiapas, aclaró que, históricamente, se le ha apoyado al campesino, “pero no ha sido de forma objetiva y efectiva por la mala aplicación de los recursos del estado; y, de forma triste, Chiapas cobra visión mundial solo por el sub comandante Marcos”.

De ahí, dijo, se observó que las mujeres indígenas ya no hacían tortillas ni transformaban el maíz, “pero hacen subcomandante Marcos de paja y lana, que es lo que el turista viene a comprar”.
Insistió en que el campesino “aprovechado” comienza a in vadir tierras, lo que se convierte en otra dotación de tierras for
ÁNGEL TORRES
zada, “pero el gobierno, en vez de proteger al productor, dice: ‘Prefiero luchar con 400 gana deros, a vérmelas con 40 mil campesinos armados’”.
Por ello, refirió que el labrie go, en la actualidad no tiene la
En Benemérito de las Américas, mejoramos la calidad de vida de las familias
capacidad para producir, y las grandes fincas que antes eran haciendas y patrimonio arqui tectónico, está perdido, pues no hubo una visión.
“Porque era decirle a esa gen te: ‘A ver, vas a crear un centro
poblacional en esta finca, pero protegerás este edifico porque es patrimonio arquitectónico de México, usufructúalo, haz un centro ecoturístico, dale de co mer a tus hijos, vamos a crear alfabetización, habrá una empa cadora, una rotación de cultivos bien aplicada’, pero hoy no hay nada de eso, ese patrimonio se ha perdido y las tierras siguen ociosas”, estableció.
De hecho, aseveró que las co lonias se convirtieron en tierras de ancianos, mujeres e infan tes, porque los jóvenes migran a Estados Unidos para trabajar de manera ilegal, luego regresan, ponen un negocio y se retornan de nuevo.
Lo peor de todo, dijo, es que no solo no se produce, no solo se invade o no solo se destruye, “sino que ahora también vamos acabar con la reserva que es un pulmón de México”.
VECINOS
Autoridades municipales tienen en el abandono las vialidades de la Colonia Albania
CARLOS LUNA - EL SIE7E
sus dos administraciones desde el 2019 hasta el año en curso.
COMUNICADO - EL SIE7E
Benemérito de las Américas.- El secreta rio de Obras Públicas del Estado, Ángel Torres, informó que a través de la cons trucción del parque central y los trabajos en la red de distribución de energía eléc trica, se hace justicia social y se contri buye al mejoramiento de la calidad de vida de las familias de Benemérito de las Américas.
Al precisar que hoy el gobernador, Rutilio Escandón Cadenas, invierte en obras de impacto social, el titular de Obras Públi cas del Estado destacó la importancia de la construcción del parque central, para que las y los habitantes puedan tener un espacio digno y de calidad para el espar cimiento y la sana convivencia. Acompañado del presidente de este mu
nicipio, Isaías Tomás Soriano Ramos, el secretario supervisó los trabajos en la red de distribución de energía eléctrica en el Barrio La Pista, en la cabecera municipal, un servicio básico que traerá desarrollo y bienestar para las familias.

En este contexto, el alcalde Isaías Tomás Soriano agradeció al gobernador Rutilio Escandón Cadenas, porque es la primera vez que un secretario de Obras Públicas visita personalmente al municipio y es la primera vez, agregó, que se realiza una inversión superior a los 30 millones de pesos en proyectos de infraestructura. Finalmente, Ángel Torres sostuvo que hoy el desarrollo y el progreso en Chia pas es una realidad, por lo que vamos a seguir trabajando, dijo, “con alma, cora zón y vida, para seguir construyendo por amor a Chiapas”.

Tuxtla.- Un grupo de vecinos de la ca lle Laurel de la colonia Albania Baja, en Tuxtla Gutiérrez, Chiapas mani fiestan que llevan más de 15 años padeciendo por la pésima condición de sus vialidades y no los atienden. Los ciudadanos afectados, aseguran que son ignorados por las autorida des municipales y que, a pesar de la documentación entregada a Obras Públicas, Oficialía de Partes y hasta a la misma Presidencia, siguen sin ser atendidos. “Realmente la colo nia Albania Baja nos tienen margina dos, en el sentido de que pues, aquí, como dicen algunos medios, obras son amores, pues queremos que nos demuestren el amor a nuestra colonia también”, agregó un vecino. Otro colono exige al presidente municipal reelecto, Carlos Morales Váz quez, en que se le dé puntual respuesta a las peticiones solici tadas desde el 2012 hasta el 11 de julio del 2022. Más de cin co documentos fueron entregados (con folios NoSOP/DP/01842021, NoSOP/DP/897/2020, NoSOP/DP/0101/2021, Sello 004521) durante
“Queremos hacer ver a las autorida des todos los oficios que hemos en tregado y no hemos tenido respuesta hasta ahorita. Un buen gobierno da seguimiento y atención a las necesi dades de su ciudadanía y que no solo en campaña aparezcan ó peor, hacer como que hacen ‘disque reparando’ pero no dan solución”, enfatizó.
La citada calle, están en pésimo es tado que prácticamente no tiene as falto, se ha deslavado al paso de los años y se ha vuelto intransitable.
En cada temporada de lluvias, se va haciendo más grande el socavón que se ha formado en el medio de la calle, inundándose también de agua, afectando a cerca de 20 familias que viven en este punto de la capital chiapaneca.
22 DE NOVIEMBRE DE 2022 SIE7E DE CHIAPAS 6 6 ESTATAL ACADEMIA NACIONAL DE HISTORIA Y GEOGRAFÍA
En Chiapas se generan oportunidades de inclusión laboral y productiva
 COMUNICADO - EL SIE7E
COMUNICADO - EL SIE7E
Tuxtla .- En un estado como Chiapas, garante de los dere chos de las mujeres, somos testigos del inicio del programa denominado “Crear es Crecer”, que tiene como finalidad gene rar oportunidades de inclusión laboral y productiva para las chiapanecas, sostuvo el dipu tado por Tapachula, Chiapas, Yamil Melgar.
En el evento realizado en la Perla del Soconusco, el tam bién presidente de la Junta de Coordinación Política del Con greso del Estado, sostuvo que este tipo de acciones permitirán mejorar la calidad de vida de los grupos de atención prioritaria como son las mujeres, promo viendo su autonomía económi ca y liderazgo emocional, esto a través de la capacitación y especialización de oficios tradi
cionales y no tradicionales. “Así como la impartición de plá ticas de sensibilización en ma teria de prevención de todo tipo de violencia; el fortalecimiento de la convivencia ciudadana y la recuperación de espacios públi cos; colocándolas como agen tes generadoras de procesos de paz en sus entornos locales”,
LÓPEZ OBRADOR
resaltó el líder del parlamento chiapaneco.
Cabe destacar -subrayó el dipu tado por MORENA- que la admi nistración que encabeza nues tro gobernador Rutilio Escandón Cadenas ha tenido un avance sustancial en temas de igualdad de género, no discriminación, y combate a eficaz a la violencia
“Lo más importante es reducir el gasto en el INE”
COMUNICADO - EL SIE7E
CDMX.- En la conferencia de prensa de este lunes, el presidente Andrés Manuel López Obrador sostuvo la importancia de reducir el gasto en el Instituto Nacional Electoral, así como el proceso de elec ción de las y los consejeros.

“Es ofensivo que ganen 400 mil pesos mensuales los consejeros, y lo otro es evitar la compra del voto, y eso lo pode mos lograr con la ley, sin la reforma a la Constitución”, expresó.
En la tradicional mañanera, López Obra dor manifestó que si bien no habrá una reforma constitucional en materia electo ral, sí habrá una legal. Aunque, apuntó, se sumaría al mecanismo actual para la elección de consejeros del INE, ya que hay que respetar la ley.
En ese sentido, insistió en explicar a quienes se oponen a la reforma constitu cional, “no tiene fundamento, la reforma es para que gaste menos, que los parti dos no tengan tanto dinero”. Actualmente el partido que más recibe es Morena. Aseveró que en la elección de consejeros del INE, “creo que quienes elijan, cual quier ciudadano, estaría mejor de los que están. Sólo por su racismo no deberían estar ahí, sólo por eso”. Agregó que la gente no lo sabe, pero seguramente con trataron a “un publicista de estos merce narios, cuentan con todos los medios y
los más susceptibles a ser manipulados caen”.
Más adelante al ser cuestionado sobre la marcha del domingo 27, el presiden te compartió que en el borrador que ya hizo del discurso no habla del tema, sino que “digo que ya no domina la oligarquía, hay democracia, el gobierno no partici pa en fraudes electorales”. Lo esencial “es cuánto tendremos de presupuesto, 8 billones, cuánto ha crecido, a cuántos mexicanos les llega ese presupuesto, a cuántas familias, cuáles son los benefi cios, algo que nunca pasaba, eso es lo más importante”.
Cabe recordar que el ejecutivo Federal adelantó la rendición de su cuarto infor me de gobierno para el 27 de noviembre, donde ha reiterado en varias ocasiones, habrá mucho que festejar por los avan ces que a la fecha a logrado la Cuarta Transformación, además de reafirmar su compromiso con los miles de militantes de Morena, para seguir llevando justicia social a los que menos tienen.
contras las mujeres, tal como ha quedado demostrado en las reformas al marco jurídico que nos rige. No omito mencionar, -enfatizo Yamil Melgar en su participación- que el Gobierno del Dr. Rutilio Escandón Cade nas, ha instruido aplicar políti cas públicas enfocadas a la pre vención social de la violencia y la delincuencia, implementando acciones estratégicas que con tribuyan al mejoramiento de la calidad de vida de los y las ta pachultecas; un ejemplo de ello es el inicio del Programa “Crear es Crecer”, ya que con la gene ración de proyectos individuales y colectivos se ampliaran los accesos y oportunidades de mujeres y hombres en cualquier etapa de su vida, para atender cada uno de sus derechos hu manos y sociales. Esa es la razón de que hoy, somos testigos de la implemen
tación de capacitaciones en Panadería Básica y la entrega de Paquetes de insumos (kits) para el desarrollo del curso an tes referido, beneficiando a 35 mujeres para el municipio de Tapachula.
En el evento desarrollado en la ciudad de Tapachula participa ron, Emma Itzel Orantes Orte ga. – Directora General del Cen tro Estatal de Prevención Social de la Violencia y Participación Ciudadana; Jorge Alberto Vega Pérez. - Subsecretario de Co mercio de la Secretaria de Eco nomía y del Trabajo; María del Rosario Uribe Barragán. - Direc tora de la Unidad de Capacita ción de Tapachula; Rosa Irene Urbina Castañeda. - Presidenta Municipal de Tapachula; Lorena Ruiz Escandón. - Beneficiaria del Programa Crear es Crecer y Jesús Domínguez CastellanosGrupo RODEVA.
BERRIOZÁBAL
Flores de Noche Buena producidas en Amendú están listas para venderse en esta temporada decembrina
REDACCIÓN - EL SIE7E
Berriozábal.- Javier Hernández Sán chez, un joven hablante de la tsotsil, expresó que en junio de este año comenzó la plantación de cuatro mil esquejes.
Lo hizo en un amplio espacio al fondo de su vivienda.

Este hombre cuida a diario cada plan ta que durante los últimos 8 años ha significado un reto para alcanzar ma yor producción.
Con ello obtiene otras especies, como es, el color rojo, rosa y blanco. Pese a que en Amendú hay carencia de agua, Javier riega a diario cada noche buena, en temporada de calor, dos o tres veces a la semana, en tem porada de lluvia.
Asimismo, las cubre y supervisa una a una para evitar la plaga.
Al igual que el resto de los habitan tes, el productor de plantas y flores, se abastece de agua que brota de una vertiente, conocida como vainilla. Posteriormente, es concentrada en un tanque del cual, las personas acu den con recipientes para llenarlos y trasladarlos a su hogar.
El próximo 28 de noviembre al 8 de diciembre, Javier deberá llevar las
flores, para su venta al tianguis do minical de Berriozabal, al igual que a otros viveros de esa región.
Para ello, tendrá que recorrer aproxi madamente 6 kilómetros de terracería para salir de su comunidad porque la carretera está en malas condiciones.
Amendú se encuentra ubicado a es casos 15 minutos de la cabecera municipal y de acuerdo al censo de población y vivienda del INEGI, es una localidad de Berriozábal, con 296 habitantes. Durante un recorrido en esa localidad, puede observarse la falta de servicios básicos y pavimen tación de calles.
22 DE NOVIEMBRE DE 2022 SIE7E DE CHIAPAS 7 ESTATAL YAMIL
MELGAR
Reconoce Rutilio Escandón a jóvenes por su trabajo, compromiso y amor a Chiapas
•Aseguró que su gobierno seguirá fortaleciendo la participación de la juventud en los ámbitos social, económico, cultural, científico y político
COMUNICADO - EL SIE7E
Tuxtla.- Al entregar el Premio Estatal de la Juventud Chiapas 2022, el gobernador Rutilio Es candón Cadenas sostuvo que su gobierno seguirá impulsando programas y acciones con el objetivo de fortalecer la partici pación e inclusión de las y los jóvenes en los ámbitos social, económico, cultural, científico y político, porque su talento, inteligencia, capacidad y crea tividad son fundamentales para lograr el bienestar y la transfor mación de Chiapas y México. “Ahora más que nunca estamos muy interesados en que realicen actividades en la búsqueda de sus sueños, esperanzas e ilu siones, y este acto significa que


se pueden hacer realidad. Nos sentimos muy orgullosos de us tedes, los vemos en crecimien to y eso nos beneficia porque representan evolución y coraje para sacar adelante las mejores expectativas de nuestra querida entidad y nación”, apuntó. Desde la explanada de Pala cio de Gobierno, el mandata rio reconoció el respaldo que el presidente de la República, Andrés Manuel López Obra dor, brinda a la juventud a tra vés de los programas Jóvenes Construyendo el Futuro y Sem brando Vida, que combaten de raíz las causas de la violencia; las becas escolares y el esta blecimiento de las Universida des Benito Juárez, con lo que se otorga a las y los jóvenes

mayores oportunidades de sa lir adelante.
A su vez, Andrés López López, ganador del Premio Estatal a la Juventud 2022, Categoría B: Fortalecimiento a la Cultu ra Indígena, en representación de los pueblos originarios y no originarios, expresó que este premio es muy especial, pues reconoce el trabajo y esfuerzo de las y los ganadores que, durante su trayectoria, reforza ron su disciplina y talento. En ese sentido, invitó a las y los jóvenes a seguir este camino y fortalecer el arte, la cultura y la ciencia, para que en unidad se genere un cambio que favo rezca al estado y al país. En su intervención, el director ge neral del Instituto Mexicano de la Juventud, Guillermo Rafael Santiago Rodríguez, destacó el trabajo que el gobierno de Rutilio Escandón desempeña a favor de las juventudes, a quie nes, dijo, hoy no sólo se premia su esfuerzo y capacidad, sino también la esperanza y el di namismo para seguir transfor mando y construyendo nuevas oportunidades de desarrollo.
“En Chiapas se reconoce a las y los jóvenes que han decidido construir una nueva historia, para que haya justicia, espe ranza y felicidad; hoy estamos en el momento histórico de la


construcción de un mejor país, donde ninguna niña, niño o jo ven se quede atrás ni afuera del bienestar”, manifestó.
La directora general del Institu to de la Juventud de Chiapas, Getsemaní Moreno Martínez, explicó que este premio, creado en 2006 y entregado consecuti vamente hasta 2015, se volvió a recuperar en 2022, gracias a que el mandatario estatal con sideró adecuado retomar la ini ciativa de reconocer a las y los jóvenes que con sus acciones impulsan y transforman al es tado en los objetivos y ejes de acción propuestos en esta con vocatoria. Detalló que en este año se
entregaron 18 premios a 32 galardonados, de los cuales 16 fueron individuales y dos colectivos, quienes enaltecen a Chiapas, por lo que las y los invitó a continuar siendo el motor de cambio en el estado. Finalmente, el representante del Comité de Dictaminación y Evaluación del Premio Estatal de la Juventud 2022, Laurent Iván Reyes Cameras, precisó que estas acciones que im pulsa el Gobierno del Estado permiten a las y los jóvenes alcanzar sus metas y logros, por ello, pidió a los participan tes invitar a más jóvenes para que, como ellos, sean ejemplo a seguir en la sociedad.
22 DE NOVIEMBRE DE 2022 SIE7E DE CHIAPAS 8 8 ESTATAL PREMIO ESTATAL DE LA JUVENTUD CHIAPAS 2022
•El gobernador entregó el Premio Estatal de la Juventud Chiapas 2022
Nacional
www.sie7edechiapas.com
México deporta a más de 100 guatemaltecos vía terrestre
EFE · EL SIE7E
Ciudad de Guatemala.- El Insti tuto Guatemalteco de Migración (IGM) registró este domingo el retorno de 112 guatemaltecos que fueron deportados por Méxi co, detenidos cuando transitaban de forma irregular en este país. Los 112 deportados fueron re cepcionados por las autorida des migratorias de Guatemala en el centro de atención de Te cún Umán, ubicado en el de partamento (provincia) de San
Marcos, frontera con México en el suroeste del territorio.
Entre el grupo enviado por Méxi co se encontraban 111 mayores de edad y un menor, retornados en un total de 3 buses, detalló el IGM.
El grupo de guatemaltecos está conformado por personas que intentaban llegar a Estados Unidos, sin embargo fueron in terceptados por las autoridades migratorias en diversos puntos del estado de Chiapas. Las autoridades migratorias se
encargan de registrar a los re tornados, posteriormente son enviados de vuelta a la región del país a la que pertenecen.
MÁS DE 35.000 DEPORTADOS VÍA TERRESTRE
Entre enero y el 20 de noviem bre, México ha deportado a 37.579 guatemaltecos, según datos del IGM.
Este año, México ha enviado más de 700 buses con migran tes hondureños y guatemalte cos a 3 puestos fronterizos del
norte de Guatemala.
Además, México deportó a 13.818 guatemaltecos por me dio de 106 vuelos entre enero y el 16 de noviembre.
Entre estos deportados se en cuentran 3.000 menores de edad que viajaban no acompa ñados.
Por su parte, Estados Unidos ha deportado a 37.051 guatemalte cos por vía aérea este año, en tre ellos 7.362 niños.
La inseguridad de la ruta migra toria en el sur mexicano se ha
convertido en una constante en los últimos meses.
Solamente el sábado, 217 gua temaltecos fueron abandonados en una zona rural de Chiapas por traficantes que supuesta mente los llevarían hasta Esta dos Unidos.

Unos tres millones de guate maltecos habitan en Estados Unidos, según la Cancillería de Guatemala, y han migrado prin cipalmente por la falta de oportu nidades económicas y la violen cia del país centroamericano.
FBI investiga muerte de una joven estadounidense en Cabo San Lucas
EFE · EL SIE7E
Los Ángeles.- El Buró Federal de In vestigaciones (FBI) abrió una inves tigación sobre la muerte de una jo ven estadounidense de 25 años que falleció en México, donde estaba de vacaciones con compañeros de su universidad.

Shanquella Robinson y otras seis personas viajaron a Cabo San Lu cas, en el extremo meridional de la Península de Baja California, en el estado mexicano de Baja California Sur, el pasado 28 de octubre para
pasar vacaciones en una residencia que alquilaron.
Robinson fue hallada inconsciente el 29 de octubre en la sala de estar de la vivienda, donde fue declarada muerta poco después ese día.
Bernard Robinson, padre de la vícti ma, dijo a CNN que la joven estaba pasando unas vacaciones con unos compañeros de la Universidad Es tatal de Winston-Salem, donde ella estudiaba.
El padre espera que los compañeros de Robinson entreguen más infor mación sobre lo que ocurrió ese día.
La Policía de Cabo San Lucas y el FBI confirmaron en comunicados a medios estadounidenses que están investigando la muerte de la joven pero no han informado de arrestos.
La causa de la muerte fue detallada como una “lesión grave de la médu la espinal”.
La muerte de Robinson fue clasifica da como “accidental o violenta”, de acuerdo con el certificado de defun ción, según el cual el tiempo aproxi mado entre la lesión y la muerte fue de 15 minutos, según documentos a los que tuvo acceso CNN.
www.sie7edechiapas.com
Martes 22 de noviembre de 2022
CINCO MESES
Jesuitas lamentan impunidad en el asesinato de sacerdotes en Chihuahua
EFE - EL SIE7E
Ciudad de México.- La comuni dad jesuita en México lamentó que, después de cinco meses del asesinato de dos sacerdotes y un guía turístico en el norte del país, el caso siga impune y que la inseguridad prevalezca en el país.
“A cinco meses del asesinato de nuestros hermanos Javier (Campos) y Joaquín (Mora), junto con Pedro Palma, los je suitas de México lamentamos que el caso siga impune y que la inseguridad prevalezca en la Sierra Tarahumara”, señalaron en un comunicado.
El 21 de junio, el propio presi dente mexicano, Andrés Manuel López Obrador, confirmó que un día antes los sacerdotes fueron asesinados dentro de una igle sia en Cerocahui, en el muni cipio de Urique, en el norteño estado mexicano de Chihuahua.
“Es una zona de bastante pre sencia de la delincuencia orga nizada. Parece que se tiene ya
información sobre los posibles responsables de estos críme nes”, sostuvo entonces.
Las muertes de los religiosos fueron condenadas por organi zaciones civiles y la comunidad

jesuita en México, que destacó que al menos siete sacerdotes han sido asesinados durante la administración del presiden te López Obrador, quien días después del asesinato prometió
PROFECO
10
una investigación “a fondo” y ofreció recompensa por el pre sunto homicida.
Sin embargo, la comunidad je suita en México señaló que, “a más de 150 días de los doloro
sos hechos, la paz no ha llega do a Cerocahui, como reciente mente declaró la Secretaría de Seguridad Pública Estatal”. En este sentido, los jesuitas enfatizaron que, “en la comuni dad prevalece la inseguridad, el miedo de que la situación quede en el olvido y de que el perpe trador regrese a la zona”.
Además, reprocharon que mien tras no haya justicia no se podrá hablar de paz y reconciliación, dos estandartes de la estrate gia de seguridad del presidente mexicano.
También aprovecharon para insistir en su llamado a los di ferentes niveles de gobierno, a fin de que se dé continuidad a la seguridad en el territorio serra no y se alcance la justicia que tanto añoran las comunidades. “Nos sumamos al manifiesto de la Diócesis de Tarahumara, quien ha convocado a construir ‘un país donde verdaderamente reine la verdad y la justicia que nos lleven a la verdadera paz y amor’”, concluyeron los jesuitas.
Computadoras, ropa y zapatos encabezan lista de reclamos en el “Buen fin”
EFE - EL SIE7E
Ciudad de México.- En el “Buen fin” en México, los com putadoras y laptops, ropa y zapatos encabezaron la lista de reclamaciones, entre 230 casos, informó la Procuradu ría Federal del Consumidor (Profeco).
La Procuraduría, encargada de vigilar que las ofertas y des cuentos se cumplan durante este evento que se realiza en el último fin largo del año, de talló que en computadores y laptops se recibieron 83 recla maciones y en el caso de ropa y zapatos 24.
La Profeco estimó que este volumen de reclamaciones por estas categorías acumulan el 46,5 % de los 230 reclamos to tales registrados.
Otros productos, como jugue tes, le siguen en la lista de re clamaciones ante Profeco, con 15 casos (6,5 %).
Por proveedores, la empresa de tecnología Hewlett-Packard (HP) México fue la que más re clamaciones recibió con 74 de las 230, seguida de la tienda de autoservicio Walmart, con 58, y la cadena de tiendas de venta al por mayor Sam’s Club, con 18 reclamos.
La Profeco explicó que de las 230 reclamaciones en los pri meros dos días del “Buen fin”, 88 fueron conciliadas, a través de la herramienta Conciliaex prés, y el resto se encuentran en proceso de solución.
En este sentido, la Procuradu ría estimó que ha recuperado en favor del consumidor un monto de 354.790 pesos (unos 17.889,5 dólares).
Entre los principales motivos de reclamación se encontraron cancelación de compra (119), incumplimiento de ofertas o promociones (34) y cobro inde bido (14).

Además, informó que otorgó
4.794 asesorías por parte del personal de la Procuraduría, relacionadas con derechos de los consumidores.
La autoridad mexicana señaló que se detectaron casos de publicidad con posible incum
plimiento en 126 casos, mien tras que atendió 169 casos de consumidores que buscaron atención por redes sociales.
El portal “El Buen Fin”, dentro de la página oficial de la Profe co, permite comparar los pre
cios de los productos de mayor demanda en esta temporada y ha recibido un acumulado de 193.917 visitas en estos dos días de ofertas y promociones similar al “Black friday” en Es tados Unidos.
22 DE NOVIEMBRE DE 2022 SIE7E DE CHIAPAS 10
A
SECTUR
México escala al puesto 29 en gasto per cápita por turismo internacional
EFE - EL SIE7E
Ciudad de México.- México se posicionará en el lugar 29 a ni vel mundial en gasto per cápita por turismo internacional, según la Organización Mundial del Tu rismo (OMT), celebró este lunes el secretario de Turismo mexi cano, Miguel Torruco.
De acuerdo con datos prelimina res de la OMT, con corte a sep tiembre pasado, México habrá de cerrar el 2021 en el segundo lugar, en llegadas de turistas in ternacionales, solo por debajo de Francia; en el noveno puesto en captación de divisas, y ahora en el lugar 29 en gasto medio per cápita.
El funcionario mexicano señaló que el incremento en el gasto medio confirma las proyeccio nes de la presente Administra ción pública mexicana, que optó por privilegiar el ingreso de divi sas por turismo internacional, e incrementar el gasto per cápita, que el número de turistas.
“Una vez más, reitero que la potencialidad de una nación no se debe medir por el nú mero de turistas, sino por las divisas captadas, y cuyos be
neficios permeen hacia las 235 plazas con vocación turística para hacer de este sector una herramienta de reconciliación social”, destacó.
Según el Barómetro Mundial de Turismo de la OMT, a septiem bre de 2022, el gasto promedio per cápita por turismo interna cional en México ascendería a 620,4 dólares, superando los 452,8 dólares de 2020.
México se colocaba en el pues to número 40 en gasto per cápi ta en 2018, con un gasto per cá pita promedio de 545,3 dólares, mientras que en 2019 escaló al lugar 37, con 545,8 dólares.
En tanto, para 2020, México solo ascendió un puesto hasta el 36, con una gasto medio per cápita de 452,8 dólares, según los datos preliminares de la OMT.
Además, el secretario Torruco consideró acertada la política de turismo implementada por el Gobierno mexicano de no restringir los vuelos internacio nales hacia México, así como todo el manejo y atención por la pandemia de la covid-19, y el apoyo del sector privado en im plementar de forma anticipada

todas las medidas sanitarias de prevención.
El titular de la Secretaría de Tu rismo de México también asegu ró que la creación de productos ancla y el desarrollo de eventos de alto impacto en los diferentes estados del país, contribuyen a la captación de más divisas y al
SADER
incremento del gasto per cápita, al adecuarse a las tendencias de un viajero más informado y exigente.
“Todo en su conjunto, dio un ex celente resultado, al grado de que al cierre del presente año, superaremos las estimaciones al recibir más de 26.121 millo
nes de dólares por turismo inter nacional, cifra récord e histórica en nuestro país, superando en 6,3 % lo obtenido en el 2019, año previo a la pandemia que trastocó la economía mundial, y cambió el perfil del turista tanto nacional como internacional”, concluyó Torruco.
Productores de sie7e estados aseguran abasto de Nochebuena en 2022
EFE - EL SIE7E
Ciudad de México.- Los principales pro ductores y comercializadores de siete estados mexicanos garantizaron el abasto nacional de distintas variedades de flor de Nochebuena, distintivas de las celebraciones de fin de año, informó la Secretaría de Agricultura y Desarro llo Rural (Sader).
Los estados que garantizaron el abasto fueron la Ciudad de México, Morelos, Puebla, Jalisco, Estado de México, Mi choacán y Oaxaca, quienes estimaron una producción para 2021 ligeramente superior a las 17,34 millones plantas que se obtuvieron el año pasado, con valor de casi 669 millones de pesos (unos 34,3 millones de dólares) y una superficie sembrada de 257 hectáreas. En 2021, a nivel municipal, la alcaldía Xochimilco, en la capital mexicana, fue líder, con una producción de 2,7 millones de plantas, seguida de Cuer navaca, en Morelos; Atlixco, en Pue bla; Tlajomulco de Zúñiga, en Jalisco, y Yautepec, en Morelos, por orden de relevancia.
Para este 2021, la Sader, el Go bierno de la Ciudad de México, productores y comercializadores contabilizaron una producción de 3,7 millones de plantas tan solo en los seis mercados y puntos prin cipales de la capital del país, con un valor de 217 millones de pesos (unos 11,13 millones de dólares).
La Alcaldía Xochimilco, en la ca pital mexicana, se mantuvo como líder en la producción de Noche buena entre todos los municipios del país con el cultivo de 2,73 millones de plantas.
En la ceremonia de arranque para la venta de Nochebuena en el país, el encargado de la Coordinación General de Agricultura de la Sader, Santiago Ar güello, señaló que este evento “es una muestra de lo que podemos hacer jun tos, autoridades y agricultores, a favor de la actividad primaria”.
Argüello destacó que la flor de Noche buena es de alto aprecio a nivel mun dial y ha llegado a países como Esta dos Unidos, España, Japón, Holanda, Alemania, Canadá, China y Francia,
entre otros.
Además, aseguró que continuará su promoción y comercialización con base en la dinámica productiva del sector, en los trabajos de mejoramiento de las variedades que se ofrecen y en la aper tura de mercados.
El encargado de la Coordinación Ge neral de Agricultura de la Sader detalló que en México se producen más de 30 variedades de esta flor, de las cuales el 90 %, tanto en producción como en consumo, corresponde a la tradicional planta con pétalos rojos, el 5 % a la blanca o amarilla, y el resto es rosa, rayada y marmoleada.

Indicó que se mantiene una cercana colaboración con productores, median te estrategias de atención con el pro grama Doctores del Suelo; capacitación en bioinsumos para la nutrición vegetal y conservación de la fertilidad del sue lo; conservación y uso sustentable de los polinizadores; rescate de maíces nativos y el proyecto estratégico Re cuperación Económica y Productiva de Plantas y Flores Ornamentales Post Covid-19, entre otras.
En su oportunidad, el presidente del Consejo Mexicano de la Flor, Federi co Martínez, aseguró que la venta de flores de Nochebuena representa para el sector el ingreso más importante de todo el año.
El presidente de Ornamental Plants & Flowers (OPF), Enrique Arias, expre só que esta “planta de buena vibra” y sus diferentes connotaciones al paso del tiempo, es un símbolo de paz y armonía, un alimento para el alma, y conlleva una actividad económica por la generación de empleos que incide en el tejido social de las zonas rura les del país.
22 DE NOVIEMBRE DE 2022 SIE7E DE CHIAPAS 11





22 DE NOVIEMBRE DE 2022 SIE7E DE CHIAPAS 12 PUBLICIDAD
Pekín.- Al menos 36 personas han muerto y dos resultaron heridas en un incendio que ha afectado a una planta tecnológica en la ciudad de Anyang (centro), informó la agencia estatal de noticias Xinhua.
Alrededor de las 16.22 hora local de este lunes (8.22 GMT) se produ jo un incendio en las instalaciones de Kaixinda Trading en el distrito de Wenfeng, o “Zona de alta tecnología”, en el cual se reportan aún dos desaparecidos.
A las 23.00 hora local (15.00 GMT), los bomberos y el equipo de rescate habían concluido las operaciones de salvamento, aunque todavía se desconocen las causas del suceso, que se hallan bajo
investigación. Vídeos del suceso que circulan por las redes sociales chinas muestran cómo una gran llamarada y columna de humo negro se originaba en el lugar del suceso.
Los heridos han sido trasladados al hospital para recibir tratamiento médico.
El suceso adquirió enseguida gran notoriedad en las diferentes redes sociales del gigante asiático, cuya etiqueta (“hashtag”) había recibido 5 millones de visualizaciones pocas horas después y donde se acu mulaban las condolencias a las víctimas y los recordatorios básicos de seguridad contra incendios.
Al menos 36 muertos por un incendio en una fábrica en China Internacional

www.sie7edechiapas.com
Sismo en Indonesia deja más de 160 muertos y cientos de heridos
EFE - EL SIE7E
Yakarta.- La cifra de fallecidos por el terremoto de magnitud 5,6 que sacudió Indonesia este lunes asciende a 162, según los datos facilitados por las autoridades locales de la provincia de Java Occidental, mientras continúa la búsqueda de supervivientes.
El gobernador de la provincia, Ridwan Kamil, cifró en 162 el número de fallecidos, en 326 los heridos y en unos 13.000 los desplazados y señaló que los datos le fueron facilita dos por la Agencia Nacional para la Gestión de Desastres
(BNPB, en indonesio).
La Agencia, que contabilizó más de 2.000 casas dañadas, mantiene, sin embargado, que hasta ahora la cifra verificada y oficial de fallecidos es de 62, confirmó un portavoz a EFE.
El seísmo se registró a las 13.21 horas (+7 GMT) del lunes cerca de la localidad de Cianjur, en la provincia de Java Occidental, la más poblada de Indonesia con casi 50 millones de habitantes.

Cianjur tiene una población de unas 170.000 personas y se encuentra a 75 kilómetros de Yakarta.
En vídeos divulgados por las autoridades locales es posible
ver decenas de personas, al gunas inconscientes, recibien do cuidados médicos y siendo trasladadas en ambulancias hacia centros de salud de la región.
Asimismo, las imágenes mues tran a varias propiedades e instalaciones dañadas, mien tras que algunas viviendas quedaron totalmente destrui das por el temblor, que llegó a ser sentido en la capital, Yakarta.
El portavoz del gobierno de Cianjur, Adam, indicó que la mayoría de las víctimas falle cieron en el hospital Sayang de esa municipalidad, donde
se sitúa el epicentro del sismo en Java Occidental.
En medio del caos y el miedo ante los corrimientos de tierra y víctimas atrapadas entre los escombros, las autoridades esperan que el número de muertos aumenten conformen pasan las horas.
Debido a los estragos causa do por el terremoto, muchas vías y carreteras de la región están cerradas y algunas esta ciones de distribución de ener gía fueron afectadas, lo que provocó cortes de electricidad en varias localidades.
Tras el sismo inicial, la Agen cia de Meteorología, Climato
logía y Geofísica (BMKG) re gistró 25 réplicas en tan solo dos horas.
Indonesia se asienta sobre el llamado Anillo de Fuego del Pacífico, una zona de gran ac tividad sísmica y volcánica en la que cada año se registran unos 7.000 terremotos, la ma yoría de ellos moderados.
Una de las catástrofes más mortíferas en el país tuvo lu gar en 2004, cuando un fuer te terremoto en el norte de la isla indonesia Sumatra generó un tsunami que causó más de 226.000 muertos en una doce na de naciones bañadas por el Océano Índico.
tv
Martes 22 de noviembre de 2022
CRISIS ENERGÉTICA
El invierno será amenaza mortal en Ucrania, indica la OMS
EFE - EL SIE7E
Copenhague.- La Organi zación Mundial de la Salud (OMS) advirtió este lunes de que millones de ucrania nos afrontan una amenaza “mortal” por los efectos de la guerra y la crisis energética provocada por los daños a la infraestructura causados por los ataques.
“La crisis energética de vastadora, el agravamiento de la emergencia sanitaria mental, las restricciones al acceso humanitario y el riesgo de infecciones vira les harán de este invierno un test formidable para el sistema de salud y para los ucranianos, pero también para el mundo y su compro miso de apoyo a Ucrania”, dijo en rueda de prensa el jefe de OMS Europa, Hans Kluge.
Kluge, que intervino de forma virtual desde Kiev, resaltó que la mitad de la infraes tructura energética del país ha sido dañada o destruida y que eso está teniendo un efecto “dominó” en el sis tema sanitario y en la salud de las personas, de ahí que el objetivo este invierno sea “sobrevivir”.

“Es el mayor ataque a la in fraestructura sanitaria en suelo europeo desde la II Guerra Mundial”, dijo Kluge, que habló de los días “más negros” en nueve meses de guerra en Ucrania desde el punto de vista de la salud.
La OMS, que no atribuye autoría ni especifica las zonas en que se han pro ducido, ha verificado hasta ahora 703 ataques a la red sanitaria ucraniana y tanto estos como los dirigidos a la infraestructura energéti ca provocan que cientos de centros de salud no estén completamente operativos, carezcan de combustible, electricidad o agua.
La falta de suministro eléctri co, que afecta a un cuarto de la población, y la amenaza del frío obligarán al uso de métodos alternativos de ca lentamiento como el carbón o los generadores, con los riesgos consiguientes por exposición a sustancias tó xicas, advierten los expertos de la OMS.
HASTA TRES MILLONES DE DESPLAZADOS MÁS
“Esperamos que entre dos y tres millones de personas abandonen sus hogares en búsqueda de calor y seguri dad”, advirtió Kluge.
El director de OMS Europa mencionó como algunas de los problemas sanitarios más urgentes el tratamiento de enfermedades crónicas, la baja cobertura de vacunas contra la covid-19 y los pro blemas mentales, que ame nazan ya a alrededor de diez millones de ucranianos.
Según reveló en la misma comparecencia el máximo representante de la OMS en Ucrania, Jarno Habicht, esta organización ha suministrado 200 toneladas de medicinas y equipamiento desde el inicio de la guerra y ya entró la se mana pasada en la localidad de Jersón, recién recuperada por las tropas ucranianas.
La OMS ayuda además for mando personal sanitario en Ucrania, suministrando estructuras prefabricadas en “áreas recientemente recu peradas” y colaborando en reparaciones de urgencia de la red sanitaria y manteni miento de energía.
A pesar de la ayuda, uno de cada cinco ucranianos tie ne problemas para acceder a medicinas y, en las zonas ocupadas o cercanas a áreas de combate, la proporción aumenta a uno de cada tres, aseguró Habicht.
NECESIDAD DE CORREDO RES HUMANITARIOS

“La guerra ha impactado el acceso a la sanidad y las líneas de suministro para el flujo de ayuda humanitaria. Ucrania necesita recursos sostenidos para que el siste ma de salud pueda pasar el invierno”, afirmó Kluge.
Kluge hizo un llamamiento a las partes a que permitan de forma “urgente” la crea ción de corredores de salud humanitarios en todas las zo nas recuperadas por Ucrania y en las ocupadas por Rusia.
“El acceso a la salud no pue de ser rehén”, denunció Kluge, quien instó también a poner fin a la guerra “antes de que el sistema sanitario y la salud de la nación ucraniana se vean aún más comprometidos”.
ESTADOS UNIDOS
El Gobierno de Biden sigue separando a niños migrantes de sus familias
EFE - EL SIE7E
Washington.- El Gobierno del pre sidente Joe Biden ha continuado la política de separación de fami lias migrantes iniciada en 2017 por su predecesor Donald Trump, según un artículo que publica hoy la revista The Texas Observer. Más de 5.500 menores de edad, incluidos bebés lactantes, fue ron separados a la fuerza de sus familias bajo un programa pilo to que se inició a comienzos de 2017 en El Paso, Texas, y fueron trasladados a diferentes partes del país.
El 20 de junio de 2018 el enton ces presidente Trump ordenó al Departamento de Seguridad Na cional que cesara esa práctica, pese a lo cual en 2019 el Pro yecto Texas de Derechos Civiles documentó 272 casos de separa ción de familias.
Durante la campaña presidencial de 2020, el demócrata Biden re pudió la política de separación de familias, y a poco de llegar a la Casa Blanca en enero de 2021 designó una comisión dedicada a ubicar a los menores de edad y a reunirlos con sus familias. A comienzos de octubre pasa
do el secretario de Seguridad Na cional, Alejandro Mayorkas, dijo que esa comisión había logrado la reunión de más de 500 menores de edad con sus familias, y todavía quedaban casi 200 niños a la espera de ese re encuentro.
Pero el artículo de The Texas Observer afirmó que, pese a las declaraciones públicas, “las au toridades de inmigración han se guido separando los niños de sus padres y madres, y desde el co mienzo del nuevo Gobierno hasta agosto de 2022 las autoridades han informado de al menos 372 casos de separación de familias”.
“The Observer ha identificado otros casos no incluidos en esta cuenta”, añadió el artículo, firma do por John Washington y Anna Catherine Brigida.
El Gobierno de Biden también ha seguido usando la norma sanita ria conocida como Título 42 -que permite la expulsión expedita de migrantes a los que se considere una amenaza para la salud públi
ca-, pero ha eximido de ella a los menores que llegan a la frontera.
“En la práctica esto ha permitido que los funcionarios de inmigra ción separen a los niños de sus familiares y custodios con impuni dad”, indicó el artículo.
La revista añadió que desde co mienzos de 2021 el Centro Legal de Defensores de Inmigrantes “ha rastreado más de 300 casos de familiares que no eran padre o madre, separados de los menores en la frontera”.
A esos menores se les catego rizó como “no acompañados” y exentos del Título 42, por lo cual pudieron permanecer en Estados Unidos al tiempo que sus acom pañantes adultos fueron enviados a México, según el reporte.
22 DE NOVIEMBRE DE 2022 SIE7E DE CHIAPAS 14 14
INTERNACIONAL
Deportes
el mundial



Se juega la NFL En México 49ers apalean a Cardinals en el Azteca en cierre de la semana once de la NFL
Arranca
de Qatar 2022 Martes 22 de noviembre de 202 2 www.sie7edechiapas.com
Faltó el brazalete, rebosaron los goles
EFE -EL SIE7E
Doha.- Sin brazalete multicolor, pero sí con goles. La selección inglesa hizo caso a su entrena dor, se centró en el fútbol y go leó a una pobre Irán (6-2), con una gran actuación de Bukayo Saka, con un doblete, de Harry Kane, en versión asistente, y de un Jude Bellingham que hizo su primer gol con los ‘Tres Leones’. “Toca hablar de fútbol”, dijo Southgate en la previa, cansado de las continúas preguntas so bre la situación catarí y el poco interés en la propia pelota. Sus quejas cayeron en saco roto, porque la previa estuvo coloni zada por el brazalete de “One Love” y su prohibición por parte de la FIFA y su veto por parte de la federación inglesa.


No hubo sorpresa de última hora y Harry Kane, amenazado de amarilla, no lució el brazale te. Quienes no se plegaron fue ron los de Carlos Queiroz, que ayudados por una afición harta de las injusticias de su país, denunciaron las barbaridades de su régimen. Los jugadores no cantaron el himno, no cele braron los goles y los carteles
de protesta en la grada fueron numerosos.
Y entre tanto lío, también hubo fútbol. Aunque quedara aparta do como casi un asunto trivial, este Inglaterra-Irán era el se gundo partido de un Mundial que está atropellando al cuero a base de escándalos.
Para enrarecer aún más el am biente, a los pocos minutos, un centro de Kane provocó una sa lida de Alireza Beyranvand, un choque con un compañero y una imagen escalofriante. Golpe mentón con mentón y el portero caído en el suelo. Tras unos diez minutos de asistencias, Beyran vand consiguió levantarse, con el tabique dañado, y para incre dulidad del respetable, siguió jugando. Duró apenas un minu to. Esta vez fueron las asisten cias, con una camilla, las que se llevaron al guardameta. Fue sustituido en el minuto 19 por Hossein Hosseini.
No se habían cumplido ni 20 minutos y habían pasado más cosas que en jornadas enteras de liga, pero faltaba el gol e In glaterra, muy cómoda ante una decepcionante Irán, encontró la puerta pasada la media hora.
El que rompió el hielo fue Ha rry Maguire, con un pase entre líneas para que Mason Mount descargara de espaldas. Ster ling, en función de catalizador abrió a la banda y Luke Shaw, que es otro cuando viste la ca miseta inglesa, puso el centro para el cabezazo bombeado de Jude Bellingham. Primer tan to con la camiseta de los ‘Tres Leones’ para el de Dortmund y una nueva presentación ante el gran público. Este chico está ya para otro nivel. El gol desarboló al ya de por
sí poco estructurado conjunto de Queiroz y en los siguientes diez minutos se fulminó el par tido. Para el 2-0 volvió a apare cer Maguire, bajando un córner, entre dos defensores, para que Saka colocase en la escuadra una volea espectacular; en el 3-0, Kane ejerció de asistente, con un centro al primer palo que embocó Sterling, el más rápido. Inglaterra lo tenía todo bajo control y llegó el 4-0 de Saka, tras desesperar a cuatro impa sibles defensas delante de él. Era un 4-0 comodísimo, pero

Inglaterra necesitó una peque ña llamada de atención. De la nada, Mehdi Taremi, el delante ro del Oporto, ganó la espalda a Maguire y empaló la pelota junto al larguero. El gol también terminó el partido del central in glés, que se tuvo que ir sustitui do por algún tipo de mareo, pero no alteró la victoria inglesa. De hecho, apenas seis minutos después del tanto iraní, Marcus Rashford, que acababa de salir al campo, recortó a un defensa dentro del área y definió cómo damente con la zurda.
De Jong inventa una victoria
EFE -EL SIE7E
Doha.- Entre la nulidad por la que se movió Países Bajos du rante 83 minutos, surgió Fren kie de Jong para inventarse un pase perfecto, remachado por la cabeza de Cody Gakpo, y crear una victoria crucial de la nada para la selección ‘oranje’, que disimuló las dudas con un premio seguramente excesivo, con tres puntos que lo ponen a la altura de lo que se esperaba de su debut, muchísimo más
productivo en el resultado que en el juego, con el 0-2 de Davy Klaasen ya a última hora Porque el triunfo no fue una cuestión única del pasador y de los dos goleadores, sino también del portero por el que apostó Louis Van Gaal para la titularidad, Andries Noppert, crucial antes, en dos paradas, para sostener el 0-0; y crucial después, con otra intervención, para aguantar el 1-0 con el que alcanza a Ecuador en la primera plaza del grupo A y con el que
da un paso adelante visible, porque en su calendario aún está enfrentarse a la débil se lección catarí.
Un golpe para Senegal, que no es sólo Sadio Mané. Si alguien había hecho méritos antes para marcar un gol había sido ella. Tampoco sin alardes. La cam peona de África asumió la pérdi da de su futbolista más determi nante, fuera de la competición más atractiva del planeta por una lesión en el peroné, con en tereza, sin atender a excusas, atrevida y valiente para abordar a Países Bajos con la presión como emblema. Lanzado arriba para contrarrestar la superiori dad técnica de su adversario, para transmitir al mundo que la baja de su mejor jugador no es definitiva, pero sí trascendente. Sin él, le falta mucho talento y desborde.
Al son de los tambores de sus aficionados, que retumbaban cada instante, cada lance, en un estadio que ganó en segui dores cuando se acercó la hora del inicio, sin aproximarse al lleno, Senegal miró de frente al partido. Ni se replegó ni se lo planteó. Contragolpe a contra golpe, ataque a ataque, jamás
especuló nada sobre el terreno de juego, aunque la diferencia de calidad entre uno y otro fue ra evidente.
A Senegal se le percibió en cuanto abordó lo más comple jo del fútbol, cuando alcanzas el borde del área, los últimos metros, cuando surge el pase, el regate o el tiro decisivo o la nada, la irrelevancia: como le ocurrió al conjunto africano en cuanto tentó la portería contra rio, en cuanto profundizó por banda, en cuanto comprobó la exigencia del Mundial para crear ocasiones, cuando sintió de forma nítida que no es lo mismo sin Sadio Mané.
22 DE NOVIEMBRE DE 2022 SIE7E DE CHIAPAS 16 16
CATAR 2022
DEPORTES
Bale debuta con gol y empate
EFE -EL SIE7E
Gareth Bale, uno de los grandes jugadores de la historia del fút bol, debutó, a los 33 años, con gol, en su primer Mundial, el de Qatar 2022. Un tanto que sólo le sirvió, no obstante, para que Galés empatase (1-1) con Esta dos Unidos, que dominó la pri mera mitad y acabó dominado por los británicos en la segunda parte de un partido entretenido. Bale, que tras abandonar el Real Madrid, acaba de ganar la Major League Soccer (MLS), la liga profesional norteameri cana, con el Los Ángeles FC -para mayor alegría del mítico Magic Johnson, leyenda de la NBA y uno de los propietarios del mismo- marcó de penalti en el minuto 82 e igualó de esa manera el tanto estadouniden se que había logrado a falta de diez minutos para el descanso Tim Weah, el hijo de George

Weah, que ganó para Libe ria el Balón de Oro de 1985. Llevaba 64 años Gales sin par ticipar en un Mundial, desde el de 1958, en Suecia; y este lu nes se estrenó, en su segunda comparecencia, la primera del ‘expreso de Cardiff’ -ganador de cinco Ligas de Campeones con el Real Madrid-, con un empate ante los Estados Uni dos. Con los que pasa a ocupar el segundo puesto del grupo B, que lidera Inglaterra; tras arra sar horas antes (6-2) a Irán. No pocos aficionados se sor prenderían al descubrir que Estados Unidos, donde el ‘soc cer’ está dando el definitivo acelerón a un proyecto que se ideó en los 70 -con el Cosmos de Pelé y Beckenbauer- y que empezó a cobrar forma a prin cipios de siglo, no sólo jugó las semifinales, sino que acabó ter cera, en el primer Mundial de la historia, en 1930 y en Uruguay.
SELECCIÓN MEXICANA
Era de aquella un deporte muy popular, jugado mayormente por el entonces muy crecien te número de inmigrantes que
poblaban el país. Pero llegó la televisión, el béisbol se con virtió en el deporte televisivo y, con ello, en fenómeno de
APOYO AL TRI
Martino se decide por Henry Lainez rompe el silencio
AGENCIAS - EL SIE7E
La Selección Mexicana saltará a la can cha del Estadio 974 de Doha, con una novedad, la del mediocampista Edson Álvarez, por lo que el tricolor de Gerar do Martino está listo para debutar este martes en Qatar 2022.
México arrancará con: Guillermo Ochoa, Jorge Sánchez, César Montes, Héctor Moreno, Jesús Gallardo, Edson Álvarez, Luis Chávez, Héctor Herrera, Hirving Lozano, Alexis Vega y Henry Martín, aseguraron a ESPN fuentes ha cia el interior de la Selección Mexicana. El timonel argentino considera que Henry Martín es la mejor opción para el primer partido de México en Qatar 2022 al mostrar en los entrenamientos un mejor desempeño que Raúl Jiménez y Rogelio Funes Mori.


Sobre Jiménez, se informó que sigue con muchos cuidados y regularmente está siendo valorado tanto por el médi co, como por el preparador físico, pero según lo que ha dejado ver el argentino
México debutará ante Polonia el martes a las 10 de la mañana, hora de México, mientras que el primer cotejo del Gru po C, entre Argentina y Arabia Saudita, está programado para las 4 am.
A pesar de no divulgar quiénes jugarán desde el inicio en Lusail, el entrenador indicó que los jugadores ya habían sido notificados en la mañana del lunes y que la alineación “no variaba de lo que se venía diciendo”. Además, confirmó que la Albiceleste no cambiará su es quema.
Las mayores dudas de Scaloni apa recían en los laterales y en el puesto que quedó ‘vacante’ tras la lesión de Giovani Lo Celso, pero tras los últimos entrenamientos en Doha se decidió por Nahuel Molina, Nicolás Tagliafico y Ale jandro “Papu” Gómez, según confirmó Diego Monroig, enviado especial de ESPN a Qatar.
AGENCIAS - EL SIE7E
El futbolista mexicano Die go Lainez se pronunció por primera vez tras quedar fuera de la convocatoria para la Copa del Mundo de Qatar 2022. El jugador del SC Braga utilizó sus redes sociales para enviar un mensaje de ánimo a los jugadores de la Selección Mexicana previo a su pri mer partido en la justa con tra Polonia.
A través de su cuenta ofi cial de Twitter, Lainez, quien fue uno de los sacri ficados de Gerardo Marti no, compartió una fotogra fía luciendo indumentaria de la Selección Mexicana y señaló que no ser conside rado para Qatar lo motiva a seguir esforzándose para cumplir sus sueños.
“Gracias a todos por el ca riño que siempre me mues tran, estoy seguro que esto será una motivación más para mi carrera y se guir en el camino tras mis sueños, no hay nada más bonito que representar a este país tan hermoso y siempre que tenga la oportunidad lo seguiré ha ciendo con la misma ilusión del primer día, los tiempos de Dios son perfectos. Todo mi apoyo para mis compañeros y amigos, que seguro nos harán sentir orgullosos a todos los mexicanos, es tamos con ustedes incondicionalmente.
Vamos México”, escribió.
Diego Lainez fue uno de los últimos jugadores que llegó a la concentración del Tri en Girona, pero el exjugador del Real Betis y América ya había sido no tificado por el cuerpo técnico de la se lección que no sería tomado en cuenta para la Copa del Mundo.
La ausencia de Lainez en la lista final fue una sorpresa para muchos aficio nados aztecas luego de que El ‘Tata’ destacara al canterano del América por su capacidad para cambiar un partido.
22 DE NOVIEMBRE DE 2022 SIE7E DE CHIAPAS 17 DEPORTES v
Gerardo Martino, el delantero nativo de Tepeji del Río, Hidalgo, estaría para ju gar en el momento que su participación sea necesaria.
GRUPO B
masas. Y el fútbol no tardó en esfumarse en Estados Unidos.
TAEKWONDO NASCAR Gladiadores gana Copa Centro Lista la semifinal
AGENCIAS - EL SIE7E
El equipo de Taekwondo Panamericano “Gladiadores” se coronó campeón de la edición 13 de la Copa Centro que se llevó a cabo este fin de semana en la Unidad Deportiva “Panchón Contreras” en Tuxtla Gutiérrez.


En entrevista, Alfredo Custodio Alvarado, organizador del evento, detalló que se dieron cita más de 800 competidores a la fiesta deportiva, que rebasó las expec tativas.
“Muy agradecida con los padres de fa milia, atletas y entrenadores por confiar y asistir a nuestro evento, vino gente de diferentes municipios, así como de los estados de Oaxaca, Veracruz y Tabasco”, declaró.
Ya acerca de las actividades, Custodio Alvarado indicó que las competencias iniciaron con la modalidad de psicomotri cidad para las categorías menores de 12 años, luego se dio paso a los combates y formas: “Fue un evento fluido, bien orga nizado para que la gente se fuera conten ta, y se rebasaron las expectativas, vino más gente de la que esperábamos y eso habla de que cada año va tomando más fuerzas nuestro torneo”.
Al finalizar las competencias, Alfredo
Custodio acompañado del presidente Nacional de Taekwondo Panamericano, Edgar Tony Abarca Cabrera, encabezó la ceremonia de premiación, donde el equipo de Gladiadores de Ocozocoautla se quedó con el trofeo de primer lugar, el segundo puesto fue para Panameri cano San Sebastián (Comitán); el tercer sitio de lo adjudicó Panamericano Inter disciplinario Tonalá; mientras que la de legación de Panamericano Agua Dulce (Veracruz) se quedó con la corona de campeón.
Cabe destacar que a la edición 13 de la Copa Centro arribaron delegaciones de Tapachula, Mapastepec, Berriozábal, Las Margaritas, Huixtla, Cintalapa, Villa Corzo, Tuxtla Gutiérrez, Jiquipilas, entre otros.
AGENCIAS - EL SIE7E
La Escudería Marzal Arzyz-Fra tech-Starkxz está lista para mostrar el poder regio en casa el próximo 27 de noviembre cuando NASCAR México Series vuelva al Autódromo Monterrey para celebrar su fecha semifinal, en donde el piloto Marcelo Ramírez tendrá una ardua batalla en la 11va fecha de Trucks México Series.

Segunda carrera en casa para Mar celo Ramírez y la Escudería Marzal Arzyz-Fratech-Starkxz, llegando en plena pelea por el título de novatos del campeonato de desarrollo, Trucks Mé xico Series, sumando hasta el momen to 321 unidades para colocarse 4to de este renglón.
A diferencia de la visita pasada a suelo regiomontano, en esta ocasión Mar celo deberá enfrentarse a un formato de circuito con su camioneta #28 Es cudería Marzal Arzyz-Fratech-Starkxz, recorriendo el trazado de 2,950 metros de longitud, a lo largo de las 35 vueltas de la competencia, el domingo 27 en punto de las 12:10 pm.
Previo a esto, tendrá una ardua jornada sabatina con par de prácticas libres y
SOFTBOL Lluvia de cuadrangulares
 AGENCIAS - EL SIE7E
AGENCIAS - EL SIE7E
Los duelos pendientes que se van dis putando en la Liga femenil de Softbol de Tuxtla Gutiérrez han dejado números im portantes en el boxscore de dichos com promisos, como fue la feria de cuadran gulares de Avíos ante Panteras, donde se despacharon con la cuchara grande, jugadoras como Marian González y María Fe García, quienes consiguieron tres cua drangulares cada una en el cloroformo del campeón ante unas felinas que se despi dieron del torneo.
Al show ofensivo de González y García, se unieron Kathy Hernández y Arantxa Solís, con dos cada una y Hazel Báez no qui so desentonar, poniendo la pelota en dos ocasiones por detrás de la malla, además de tener otra buena salida a la placa para colaborar a un triunfo que ya coloca al campeón con 14 triunfos con únicamente dos derrotas y dos juegos por disputar, para concluir formalmente la etapa regular de este torneo.
38 carreras a dos fue el resultado final de este encuentro, que únicamente disputó tres entradas y que dejó todo en su sitio, el mejor equipo de la temporada regular, contra el debutante que se despidió de su primer torneo y que, con mucha seguridad, volverá con mejores expectativas para cuando regresen a otro torneo de la pelota blanda femenil.
En otro compromiso que se disputó este domingo, Apaches se midió a la novena de Ámbar, en compromiso que arrancó bien, con Ámbar tomando la ventaja, pero Apaches demostró que es un equipo muy competitivo y consiguió el triunfo con pi zarra de 13 carreras a 6, con lo que se consolida en el segundo sitio, que deberá mantener en los dos duelos que le restan para completar su estadística y pensar en el arranque de las finales, que están contempladas para el inicio del 2023, no sin antes revisar a detalle que las novenas cumplan con lo solicitado para completar su presencia en dicha etapa.
sesión clasificatoria en donde se de cidirán los lugares de arrancada para esta que representa el episodio semifi nal de un calendario que comprende 12 fechas totales.
“Siempre contento de correr en casa, es una gran oportunidad para mostrar me ante la afición regia. Sin duda es algo que me motiva demasiado para buscar un gran fin de semana”.
“Ahora tocará probar en el circuito, es perando que se mantenga el clima que hasta el momento no ha sido caluroso, eso nos ayudaría a sacar un mejor ren dimiento de la camioneta”.
Será este 27 de noviembre cuando Marcelo Ramírez se presente de nueva cuenta en casa, para encarar la fecha semifinal de Trucks México Series, du rante la visita de NASCAR México Se ries al Autódromo Monterrey.
PODIUM
Bronce cerró cosecha
“Es un trabajo que todos hemos hecho, hay que aplaudir a mis compañeros que lo lograron. Y lo más importante el apoyo de CONADE y de la Federación y de los profesores siempre hay que aplaudir eso. Siempre se los voy a reconocer porque ellos están al pendiente de nuestras necesida des”, dijo a la Comisión Nacional de Cultura Física y Deporte. Indicó que ser parte de los meda llistas de este Mundial es un lo gro más en su carrera deportiva, ya que por segunda vez de ma nera consecutiva sube al podio, aunque lo ideal hubiera sido la obtención del título tras la plata conseguida en Manchester, In glaterra, en el 2019.
AGENCIAS - EL SIE7E
En una batalla de alto calibre, en la categoría menos de 58 ki logramos, el deportista quereta no Brando Plaza Hernández, se quedó con la medalla de bronce al caer ante el monarca de los Juegos Olímpicos Tokio 2020, el italiano Vito Dell´Aquila, por 0-2 (0-6 y 3-16) en el Campeonato Mundial de Taekwondo Guadala jara 2022 y con ello México pasó la historia al obtener seis presas y terminar como monarca de la competición.
“Me tiene feliz, me quede con ese sabor de boca en mi pelea con el italiano, lo conozco, uno siempre quiere más y ahora hay que levantarse porque el próximo año se vienen eventos importantes para seguir dejando a México en lo alto”, afirmó.
El también subcampeón pana mericano de Lima 2019, externó que a pesar de haber tenido una larga semana de espera, “me siento contento por lo logrado y además porque siempre apoye a mis compañeros para motivarlos y sentir la misma vibra”.
22 DE NOVIEMBRE DE 2022 SIE7E DE CHIAPAS 18 18
DEPORTES
BEISBOL PACÍFICO
Hay 14 candidatos más Yaquis en buena racha
AGENCIAS - EL SIE7E
Carlos Beltrán, John Lackey y Jered Weaver figuran entre 14 nombres nuevos en la papeleta de candidatos al Salón de la Fama, en lo que podría constituir una consulta sobre el efecto del escándalo de trampas de los Houston Astros en el voto de la Asociación de Cronistas de Béisbol de Norteamérica (BBWAA).

R.A. Dickey, Huston Street, el venezola no Francisco Rodríguez, Bronson Arroyo y Matt Cain figuran también en la pape leta, junto con Jacoby Ellsbury, Jayson Werth, Mike Napoli, J.J. Hardy, el domi nicano Jhonny Peralta y Andre Ethier, in formaron el lunes el Salón de la Fama y la BBWAA.
Entre los candidatos que aparecieron ya en votaciones anteriores están Scott Rolen, Todd Helton y Billy Wagner. Rolen recibió 249 de 394 votos el año pasado (63,2%), cuando el dominicano David Or tiz fue elegido con 307 votos (77,9%), 11 más que el 75% requerido.
Helton se quedó en 205 votos (52%) y Wagner en 201 (51%).
Los votantes desairaron a varios astros cuya carrera fue marcada por los esteroi des y otros escándalos.
Barry Bonds (260 votos, 66%), Roger
Clemens (257, 65,2%) y Curt Schilling (231, 58,6%) fueron retirados de la pape leta, un año después de cumplir 10 apari ciones. En cambio, aparecerán en la lista del comité de béisbol de la era contem poránea, que se reúne el 4 de diciembre en San Diego, antes de las reuniones in vernales de las Grandes Ligas.
AGENCIAS - EL SIE7E
Faustino Carrera se impuso a Manny Barreda en un duelo de lanzadores, y los Yaquis de Ciudad Obregón vencie ron este sábado por 4-2 a los Tomate ros de Culiacán, para extender a seis su racha de victorias en la Liga Mexica na del Pacífico, a un juego de finalizar la primera vuelta.

Carrera se anotó la victoria tras admi tir cinco imparables y dos carreras en seis capítulos con siete abanicados, mientras que la derrota fue a la foja de Barreda, que completó seis entradas de seis hits, tres anotaciones y siete abanicados.
Víctor Mendoza bateó de 4-3 con un doble y dos carreras producidas, Yadir Drake se fue de 3-1 con una remolcada y Taiki Sekine bateó de 3-2 con un tri ple y dos anotadas para destacarse en la ofensiva de los Yaquis.
En Monterrey, los Sultanes barrieron a los Águilas de Mexicali en una doble cartelera de encuentros recortados a siete episodios.
En el primer encuentro de la tarde, Cristian Castillo tuvo una dominante salida para guiar a los Sultanes a una
victoria por 6-0 sobre los Águilas. Castillo completó cinco episodios en blanco de apenas cuatro imparables para llevarse la victoria, mientras que el revés fue al registro de Marcelo Mar tínez, tras tolerar cinco hits y cuatro anotaciones en dos innings y dos ter cios.
Ricardo Serrano bateó de 3-2 con un doble y dos carreras producidas, Ro berto Valenzuela se fue de 4-2 con una remolcada y Jared Oliva de 3-2 con un doble y una empujada para destacarse en la ofensiva de los Sultanes.
NBA
Ja Morant en duda
AGENCIAS - EL SIE7E
El base de los Memphis Grizzlies, Ja Mo rant, fue diagnosticado con un esguince de tobillo izquierdo de grado 1 y su estado se revisará “semana a semana”, anunció el equipo el sábado.

Morant sufrió la lesión al final de la victoria del viernes sobre el Oklahoma City Thun der después de ‘enredarse’ con el escolta del Thunder, Lu Dort. Morant cayó con do lor de inmediato y tuvo que ser ayudado a salir de la cancha.
Memphis ya perdió al escolta Desmond Bane, a quien le diagnosticaron un es guince de grado 2 en el dedo gordo del pie derecho a principios de esta semana. El equipo dijo en ese momento que sería reevaluado en dos o tres semanas.
Morant, de 23 años, promedia 28.6 pun tos y 7.1 asistencias en lo que va de esta temporada.
El guardia de los Philadelphia 76ers, Tyre se Maxey, sufrió una pequeña fractura en el pie izquierdo y se espera que se pierda de tres a cuatro semanas, dijeron fuentes a Adrian Wojnarowski de ESPN.
Maxey sufrió la lesión con 1 minuto, 36 se gundos para el final de la primera mitad de la victoria del viernes sobre los Milwaukee Bucks, cuando cayó mientras recibía una falta en la transición.
Después de que los Sixers cometieran una falta intencional, Maxey salió cojeando de la cancha y regresó al vestidor de Filadel fia. Luego, el equipo lo descartó para el resto del juego al comienzo de la segunda mitad.
TRAYECTORIA
Espinoza recuerda el camino
AGENCIAS - EL SIE7E

La sinaloense María del Rosario Espinoza, escribió una historia gloriosa dentro del taekwondo mexicano gracias a su talento y en trega en una actividad que empezó como un juego en su natal Guasave y que, con el paso del tiempo, lo gró ganarse un lugar en el contexto internacional con tres medallas olímpicas y mundiales.
“Me siento tranquila porque he terminado con una eta pa de mi vida, para iniciar otra, pero siempre ligada al deporte. Contenta por todo lo que el taekwondo me dio”, dijo la ahora excompetidora a la Comisión Nacional de Cultura Física y Deporte (CONADE).
Durante el homenaje en el marco del Campeonato Mundial de Taekwondo Guadalajara 2022, que marcó su retiro de manera oficial de los tatamis, María Espinoza destacó que a lo largo de su vida deportiva vivió una serie etapas en las cuales supo valorar el trabajo de todos los días para llegar a lo más alto del podio.
“Me dio la oportunidad de representar a México en cada una de mis competen cias en donde puse la bandera de mi país en lo más alto, fueron momentos grandiosos”, apuntó.
La sinaloense logró todo lo que se pro puso. Obtuvo las tres medallas de los torneos más importantes del orbe. En el 2007 a los 20 años, logró ser monar ca mundial en la cita en Beijing, Chi na, en donde un año después subía al podio, pero ahora en Juegos Olímpicos en la misma ciudad.
Su grandeza comenzaba a sobresalir en el contexto internacional, ya que en Londres 2012, donde portó el lábaro patrio como abanderada de la delega ción nacional, volvía a figurar en una cita veraniega con una plata y en Río 2016, sumaba la tercera presea olímpi ca, pero ahora de bronce; se convertía en la histórica medallista.
Pudo haber asistido a Tokio 2020, pero el destino determinó que era el momen to de dar paso a otra historia.
22 DE NOVIEMBRE DE 2022 SIE7E DE CHIAPAS 19 DEPORTES
Dominando vallas
AUTOMOVILISMO
El consuelo de Pérez y RedBull
AGENCIAS · EL SIE7E
El jefe de Red Bull, Christian Horner, destacó la labor que realizó Checo Pérez a lo largo de la temporada 2022 en la cual el mexicano sumó 305 puntos y obtuvo dos victorias y su primera pole en la Fórmula 1.

El mexicano peleó hasta la última carrera por la segunda po sición del campeonato de pilotos, ante esto, Christian Horner mencionó que “Checo debe sentirse orgulloso de lo que ha logrado este año”.
Sobre el aporte que tuvo Sergio Pérez para la obtención del campeonato mundial de constructores y ayudar a Max Versta ppen a convertirse en campeón mundial señaló que “Ha con tribuido en los logros obtenidos por el equipo y el tercer lugar es un gran resultado. Ahora solo queda pensar en el 2023 que para nosotros comienza mañana”.
Christian Horner mencionó que Checo Pérez habría termina do en la segunda posición en el Gran Premio de Abu Dabi si esta hubiera tenido una vuelta más, ya que en el giro final se quedó a 1.4 segundos de superar a Charles Leclerc. “Quizá con una vuelta más lo hubiéramos conseguido, pero el daño estuvo hecho en la primera tanda donde tuvo mayor degradación. Después fuimos a dos paradas para atacar y le faltó una vuelta. Una temporada fantástica para el equipo. Ha
sido increíble y el equipo lo hizo fantásticamente bien. Logra mos 17 victorias, triunfos sprint, campeonatos de pilotos y constructores”, externó.
“Hemos tenido altibajos en el camino, pero cuando miras atrás será una temporada difícil de igualar. Seguiremos em pujando y luchando. Ha sido un equipo fantástico con mucha profundidad en pista, pilotos, fábrica y es un trabajo duro”, dijo a DAZN.
LA COLUMNA SIEMPRE CON ATENCIÓN

 ANNETE LEWIS DEPORTE@ SIE7EDECHIAPAS.COM.MX
ANNETE LEWIS DEPORTE@ SIE7EDECHIAPAS.COM.MX

Seguir el mundial no es fácil, las co berturas son complejas y cada vez es más preponderante la oportunidad de hacer negocio que la de difundir de buena forma el que se considera el evento más importante en el ámbito deportivo. No hay competencia en tre el Mundial de futbol y los Juegos Olímpicos y cuando hay quien afirma que el Súper Bowl o algún otro mo mento de la actividad, no tiene tanta base como para no ver lo que mueve el futbol.
Pero decían por ahí que, Qatar es tan pobre futbolísticamente hablan do, que lo único que tiene es dinero, pero hasta eso se va cambiando de perspectiva cuando se descubre que sí, cuando parecía que la opulencia iba caracterizar la competencia, no hay duda que de a poco va cambiando todo, les faltará siempre esa dosis de pasión que siempre es limitada por los temas culturales y de otra índole que condiciones al futbol.
El balompié tiene pasión, tiene san gre y tiene también otros detalles que siempre va a ir de la mano, y que en Qatar están ausentes.
Dicen que la primera desazón se dio justo cuando los equipos pensaron en portar un brazalete con los colores del arco iris, para apoyar las causas que corresponden y que, en Qatar, como en otras zonas del mundo, no tienen sitio; sin embargo, los futbolis tas pensaron que se podía usar. No hubo manera, porque FIFA encontró en el reglamento una situación para evitarlo, existen pues códigos de ves timenta en la cancha y portar algo que no se consideró en su momento, abría la puerta para polemizar. Qatar no ve con buenos ojos esos temas; es más, existe una prohibición de hacerse muestras de cariño en público y eso se va juntando con otras cuestiones que hacen inexplicable cualquier si tuación de otorgar sedes a mansalva y condicionados por el dinero.
Ya en lo futbolístico, no hay que echar las campanas al vuelo con Inglaterra, Irán no está cerca de ser un paráme tro, pero es responsabilidad entera de los ingleses aprovechar las circuns tancias que se van presentando y una de ellas era golear al más débil del grupo. Ya vendrán pruebas importan tes.
Holanda sin complicarse, Países Bajos fue práctico y dejó jugar a Senegal, lo mató cuando pudo y Estados Unidos, como en los últimos mundiales, sabo teándose solos, tuvieron ventaja, pero no consiguieron ganar y todo estará más complicado desde ahora.
22 DE NOVIEMBRE DE 2022 SIE7E DE CHIAPAS
La ucraniana Viktoriya Tkachuk cumplió recién 28 años y va acumulando cada vez mejores tiempos en sus com petencias.
DEPORTES
IMAGEN DEL DÍA
Código Rojo
Martes 22 de noviembre de 2022 www.sie7edechiapas.com
Corte de circulación deja dos heridos
Tuxtla.-Al menos dos personas resul taron malheridas durante un aparatoso accidente carretero suscitado sobre la vía Tuxtla-Chiapa de Corzo y retornó de Cahuaré, durante la mañana de ayer. El hecho fue registrado alrededor de las 06:40 horas, cuando elementos de Trán sito del Estado, arribaron al citado sitio. En el lugar, se informó que, un vehículo deportivo de la marca Corvette y láminas de circulación del Estado de México in tentó dar vuelta en el retorno. Esto, ocasionó que, terminara estrellán dose contra un taxi de Chiapa de Corzo y


con número económico 020.
Derivado de estos hechos, los daños materiales fueron cuantiosos además de que, dos ocupantes del transporte públi co resultaran malheridas.
Minutos después, una ambulancia de la Cruz Roja Mexicana de esta localidad se constituyeron y auxiliaron a los heridos, trasladandolos a un nosocomio en la ciu dad capital.
Una hora más tarde, dos grúas con pla taformas se encargaron de remolcar las unidades involucradas y fueron remitidas al corralón en turno.
Trascendió que, los heridos aún se en cuentran recibiendo atención médica especializada pues el mayor impacto, lo sufrieron en sus cráneos.
AGENCIAS -EL SIE7E
Se quedó dormido y se estrella en una fila de carros
AGENCIAS · EL SIE7E
Tuxtla.-Un “pestañazo” hizo que, un automovilista terminara estrellándose contra varios ve hículos sobre la Calzada Arbole das de la colonia Patria Nueva, ocasionando únicamente, daños materiales cuantiosos.

El reporte fue proporcionado alrededor de las 23:40 horas, cuando elementos de Tránsito y Vialidad Municipal informó que, una camioneta de la marca Audi y en color negro, se desplazaba
de Sur a Norte.
Sin embargo, de acuerdo con información de las propias auto ridades, el conductor se quedó dormido mientras conducía. Esto, lo llevó a estrellarse contra varias unidades motrices apar cadas (una motocicleta de la marca Italika, una unidad Suzu ki, un vehículo compacto de la marca Volkswagen y finalmente contra la acera).
Agentes viales puntualizaron que, no se reportaron personas lesionadas en el sitio, solamente
los daños materiales. Una hora más tarde, dos grúas con plataforma se encargaron de remolcar las unidades particula res para finalmente, remitirlas al corralón en turno.
Muere sujeto en las calles de Teopisca
VANESA RODRIGUEZ-EL SIE7E
Teopisca.- Un sujeto del sexo masculino, fue encontrado sin vida en las afueras del auditorio de basquetbol de la cabecea mu nicipal de Teopisca, la mañana de este lunes, El hombre presuntamente tenía problemas con el consumo de al cohol y deambulaba por las calles. Personas que pasaban por la ca lle dieron parte a los elementos de Protección Civil y al acudir al lu gar que se ubica en la 1a calle sur oriente, esquina con la carretera internacional 190, se percataron que un sujeto se encontraba sen tado sin signos vitales.
Al lugar acudieron elementos de la Policía Municipal de Teopisca, quienes acordonaron la zona a espera de los elementos del Mi nisterio Público para el levanta miento del cuerpo.
Los primeros indicios indican que pudo haber perdido la vida por congestión alcohólica e hipoter mia, y hasta el cierre de la edición se encontraba en calidad desco nocido, llevado por elementos del Ministerio Público, al descanso del velatorio municipal.
Aprehenden a mujer por robo con violencia en Tapachula
COMUNICADO EL SIE7E
Tuxtla.- Hace un momento, la Fiscalía General del Estado (FGE) a través de la Fiscalía de Distrito Fronterizo Costa cumplimentó orden de apre hensión en el municipio de Ta pachula en contra de Veronica “N” como presunta responsa ble del delito de Robo con Vio lencia Agravado, cometido en agravio de persona del sexo femenino.
Elementos de la Policía de In vestigación de la FGE dieron cumplimiento a la orden de aprehensión, emitida por el Juzgado de Control con sede en Tapachula.

La presunta responsable fue puesta a disposición del Juez que la reclama para que de termine su situación jurídica en las próximas horas al inte rior del CERSS número 04 con sede en esta localidad, por ilí cito cometido el pasado 18 de
diciembre de 2020.
De acuerdo con la carpeta de investigación, la imputada
despojó con violencia dinero en efectivo a la agraviada, he cho ocurrido en Tapachula.
Sentencian a 5 años de prisión a violador en Huixtla

COMUNICADO
EL SIE7E
Tuxtla.- Este día, la Fiscalía Ge neral del Estado (FGE) a través de la Fiscalía de Distrito Fronte rizo Costa obtuvo sentencia con denatoria de cinco años y cuatro
meses de prisión en contra de Os bely “N”, por el delito de Violación, hecho ocurrido en el municipio de Huixtla en agravio de una persona del sexo femenino de identidad protegi da en el año 2021. En audiencia, el Juzgado de Con trol de Huixtla, dictó la sentencia condenatoria im poniendo dicha pena, que deberá compurgar al inte rior del Centro Es tatal de Reinser ción Social para Sentenciados número 07 con sede en Huixtla.

De acuerdo con la causa penal, Osbely “N” agredió sexualmen te a la víctima (adolescente) al interior de un domicilio, el 23 de enero de 2021, hecho ocurrido en dicha localidad.

22 DE NOVIEMBRE DE 2022 SIE7E DE CHIAPAS 22 22

22 DE NOVIEMBRE DE 2022 SIE7E DE CHIAPAS 23 PUBLICIDAD
49ers apalean a Cardinals
 EFE · EL SIE7E
EFE · EL SIE7E
CDMX.- Los San Francisco 49ers apalearon este lunes 38-10 a los Arizona Cardinals en el Estadio Azteca de la Ciudad de México en duelo que ce rró la semana 11 de la temporada 2022 de la NFL. Con la victoria los 49ers arribaron al primer lugar del Oeste de la NFC con seis ganados y cuatro perdidos; Arizona se quedó en el tercer puesto, en la misma división, con marca de 4-7.
Jimmy Garoppolo tuvo una destacada actuación; pasó para 228 yardas y cuatro pases de anota ción. También brillaron George Kittle y Brandon Aiyuk, recibieron dos envíos de touchdown cada uno.
Con Arizona el quarteerback Colt McCoy, respal do de Kyler Murray, lesionado, sumó 218 yardas y una intercepción.

En el primer cuarto la defensiva de 49ers, número uno de la liga y motivada por la mayoría de los más de 78.427 aficionados en el Azteca, mantuvo a raya a la ofensiva de Cardinals que sólo sumó un gol de campo.
En el arranque del segundo cuarto la ofensiva liderada por Garoppolo arrastró 82 yardas a Ari zona; culminó su serie con pase de anotación de siete yardas a Brandon Aiyuk para dar la vuelta 7-3.
En el intento de respuesta la defensiva de San Francisco detuvo al ataque rival con la intercep ción de Jimmie Ward que dejó a la ofensiva de los gambusinos en la yarda 46 del oponente.
Los 49ers no desaprovecharon la posición de te rreno; convirtieron siete puntos con un envío de 39 yardas de Garoppolo hacia George Kittle que los alejó 14-3.

El equipo dirigido por el entrenador Kliff Kings bury apretó el resultado 14-10 con una acarreo de James Conner antes del descanso.

San Francisco alargó su dominio en la primera serie del tercer cuarto con una reversible que Deebo Samuel llevó a las diagonales; escapó 39 yardas y colocó a su equipo 24-10.
Arizona no encontró la forma de frenar los aca rreos de Elijah Mitchell y Deebo Samuel, combi nados con los envíos a McCaffrey que llevaron a los gambusinos a otra anotación por pase para Brandon Aiyuk, su segunda del juego y sexta del año, que los puso 31-10.
En modo demoledor los 49ers sumaron siete pun tos más con un nuevo envío a las diagonales para Kittle, su segundo del juego, que selló el 38-10.
El mexicano Will Hernández, guardia titular de los Cardinals, no jugó por una lesión en el músculo pectoral que sufrió en la semana 9, que lo tendrá fuera hasta la primera quincena de diciembre.
Fue la segunda vez en la historia que estos equi pos se enfrentaron en el Estadio Azteca, la pri mera fue en el 2005, en aquella ocasión Arizona venció por 31-14.
El 49ers-Cardinals en la Ciudad de México fue el último de la serie de cinco partidos internaciona les que la NFL programó este año. Los primeros tres fueron en Londres y el cuarto en Múnich.
22 DE NOVIEMBRE DE 2022 SIE7E DE CHIAPAS 24 DEPORTES
en
RESULTADOS Chiefs 30 - 27 Chargers Bengals 37- 30 Steelers Cowboys 40 - 3 Vikings Raiders 22 - 16 Broncos Commanders 23 - 10 Texans Panthers 3- 13 Ravens Lions 31 - 18 Giants Rams 20- 27 Saints Jets 3 -10 Patriots Eagles 17- 16 Colts Browns 23- 31 Bills Bears 24-27 Falcons Titans 27 - 17 Packers 49ers 38 - 10 Cardinals NFL
en el Azteca
cierre de la semana once de la NFL
QB Zach Wilson
Tres semanas después de decir que Wilson sería el titular por el resto de la temporada, salvo una lesión, Saleh no se comprometió el lunes sobre si la segunda selección ge neral de 2021 comenzará el domingo contra los Chicago Bears.
RB Michel Carter
Los Jets se recargarán en Michael Carter y Ty Johnson como sus dos mejores corredores. Carter, el corredor líder del 2021 para los Jets, de hecho arrancó la campaña como el corredor primordial, antes de ceder el paso a Hall. Zonovan Knight, un novato no reclutado procedente de NC State, probablemente será elevado desde la escuadra de prácticas para aportar profundidad.
WR Core Davis
Zach Wilson extrañará a Corey Davis, uno de sus recep tores más confiables. En siete juegos, tiene 19 recepciones para 351 yardas y dos anotaciones ,Saleh dijo que confía en que Davis regresará en la Semana 11, luego del adiós de la próxima semana.
SALUD
Entrega Rutilio Escandón aparatos de alta tecnología a Centrales de Equipo y Esterilización de hospitales
COMUNICADOEL SIE7E
Tuxtla.- Al fortalecer tecnológicamente las Centrales de Equipo y Esterilización de di ferentes unidades médicas hospitalarias, el gobernador Rutilio Escandón Cadenas aseguró que estas acciones se realizan con el objetivo de contar con lo necesario para ofrecer servicios de salud de calidad y que nadie se quede sin poder recibirlos. “La Central de Equipo y Esterilización es el corazón de todos los hospitales, pues si los instrumentos para la salud no se tienen en óptimas condiciones, cómo garantiza mos que las cirugías sean de alto nivel. Me emociona mucho que, en menos de cuatro años, hemos avanzado de manera fuerte en salud y no vamos a escatimar ni recur sos ni esfuerzos al atender este rubro”, enfatizó.



En este sentido, resaltó la reconversión de unidades médicas, la disminución de la muerte materna, los cero casos de muertes por dengue en los últimos años, la insta lación de la red de frío en los 10 Distritos de Salud, el abasto de medicamentos, la procuración de órganos en espacios y con equipos adecuados para recibir esta gene rosidad del pueblo chiapaneco que, dijo, cada vez se suma más a una nueva cultura de donación de órganos.
El secretario de Salud, José Manuel Cruz Castellanos, señaló que este proyecto ha permitido hasta el momento 22 autoclaves instaladas, 17 actualizaciones, dos man tenimientos y 13 pendientes por instalar; esto, precisó, en hospitales generales, bá sicos comunitarios y centros de salud con hospitalización y servicios ampliados. Agregó que de esta forma se moderniza la atención al brindar un servicio eficiente en el proceso de esterilización, gracias a que contarán con autoclaves de nuevo uso, que son aparatos con tecnología de prime ra, con una duración mayor a 10 años. Por su parte, la jefa de enfermeras del Hospital General Juárez, del municipio de Arriaga, Edna Leonor Aguilar Amores, re lató que en sus 26 años de servicio nunca habían recibido autoclaves de nuevo uso, sin embargo, en esta administración les han brindado dos y de excelente calidad. En representación de sus compañeras y compañeros agradeció a quienes hicieron posible el equipamiento del hospital y se comprometió a hacer buen uso.
Finalmente, la diputada Martha Verónica Alcázar Cordero, presidenta de la Comi sión de Salubridad y Asistencia del Con greso del Estado, subrayó que gracias al trabajo y dedicación del gobernador Rutilio Escandón y el impulso del presidente de la República, Andrés Manuel López Obrador, se ha logrado la transformación del sistema de salud y un nuevo rostro en las unidades médicas, lo que permite una atención con servicios dignos, seguros y de calidad.
•El gobernador resal tó los avances que ha habido en los últimos cuatro años en materia de salud, y aseguró que se continuará invirtien do en este rubro
•Se entregaron auto claves nuevas, que son aparatos para completar la tarea de esterilización de equipo
22 DE NOVIEMBRE DE 2022 SIE7E DE CHIAPAS 25 ESTATAL
SAN CRISTÓBAL
Agradecen gestiones de camino al parque Ecoturístico El Arcotete
VANESA RODRÍGUEZ - EL SIE7E
SCLC.- Autoridades de la comunidad Río Arcotete, municipio de San Cris tóbal, agradecieron las gestiones que hiciera la Diputada por este Distrito, Fabiola Ricci Diestel, luego de que en una asamblea este fin de semana, en tregará el escrito de priorización de obra de camino signado por la Comisión de Caminos e Infraestructura Hidráulica, el cual ya está agendado para su ejecución en el 2023

Durante su intervención, Eladio Hernán dez Hernández, Agente de la Comuni dad, agradeció el respaldo de la legisla dora, quien desde que asumió el cargo, a trabajado de la mano para las gestio nes en el mejoramiento de un tramo ca rretero que ayudará a un mejor acceso a los miles de turistas que llegan al parque Ecoturístico El Arcotete.
En su intervención, Fabiola Ricci, des tacó la intervención del Gobernador de Chiapas, Rutilio Escandón Cadenas, para dar prioridad a esta obra en el 2023, y que se espera ya no sea solo el tramo que estaban gestionando, sino un poco más, logrando con esto que en temporada de lluvias, los turistas tengan un mejor acceso.
“Hemos estado caminando y tocando puertas con ustedes, a principios de
este año estuve con ustedes, cuando entregamos el permiso de Protección Civil para empezar la gestión de esta carretera, fue un trabajo que concluimos con sus autoridades, hoy entregó un do cumento de priorización de la obra, don de el gobernador estuvo muy pendiente del tema, al igual que el secretario de obras en el estado de Chiapas”, dijo. Aplaudió que esta comunidad se man tenga unida como lo han venido hacien do para lograr temas en común, además de comprometerse seguir trabajando con las autoridades que tomarán el cargo el próximo 23 de diciembre Elías López López, agente rural; Manuel López López, suplente; y Rigoberto Méndez Gómez, presidente del patronato de ca minos, sustituyendo a Eladio Hernández Hernández, Mario Gómez López y Julio Cesar Díaz Díaz, respectivamente.

SECRETARÍA DE SALUD


En las últimas horas, 4 casos de COVID-19 en Chiapas
COMUNICADO - EL SIE7E
Tuxtla .- La Secretaría de Salud del estado da a conocer el reporte de cua tro casos de COVID-19 en las últimas horas, sin la notificación de defuncio nes a causa de esta enfermedad res piratoria. De acuerdo con el panorama epidemiológico más reciente, los con tagios de COVID-19 se registraron en tan sólo dos municipios de la entidad:
Tuxtla Gutiérrez con tres casos y Re forma con uno.
Se trata de cuatro personas del sexo masculino, mayores de 30 años de edad, de las cuales sólo una está libre de factores de riesgo, mientras que el resto presenta padecimientos adi cionales como diabetes, enfermedad pulmonar obstructiva crónica, hiper tensión, inmunosupresión, tabaquismo e/o hipertensión.
22 DE NOVIEMBRE DE 2022 SIE7E DE CHIAPAS 26 26 ESTATAL
MORENA
Surgen más voces en favor de Adán Augusto, el presidenciable favorito
COMUNICADO - EL SIE7E
CDMX.- En últimas fechas se han pronunciado más sectores sociales, políticos, empresa riales y religiosos, cámaras y colegios, que respaldan al se cretario de Gobernación, Adán Augusto López Hernández, para que sea candidato presi denciable por Morena rumbo al 2024.
Este fin de semana, Adán Xicale Huitle, excandidato del Partido Encuentro Social (PES) a la al caldía de San Andrés Cholula, en Puebla, encabezó el Frente Obradorista Sanandreseño, con el que promoverá la candidatura presidencial de Adán Augusto López Hernández.

“Hoy quienes integramos el Frente Obradorista Sanandre seño convocamos a los cholul tecas a participar en unidad a la marcha del 27 de noviembre, convocada por Andrés Manuel López Obrador en la Ciudad de México, así como nuestra
integración al proyecto políti co nacional ‘Que siga López, estamos Augusto”, expresó el activista social en Twitter. Asi mismo, grupos civiles del esta do de San Luis Potosí crearon la Asociación Civil denominada “Transformación en Paz y Li bertad”, que busca construir una base y una estructura para impulsar al titular de Segob, Adán Augusto López Hernán dez, como candidato de More na a la presidencia de México en el 2024.
Recientemente, el coordinador nacional de la Alianza Patriótica por la 4T, Ricardo Peralta exhor tó a respaldar a Adán Augusto López Hernández, para conti nuar con el proyecto de la Cuar ta Transformación que encabe za el presidente Andrés Manuel López Obrador.
“Adán Augusto López Hernán dez es el único que puede ga rantizar el proyecto de transfor mación del país, emprendido por Andrés Manuel López Obra
PAZ Y SEGURIDAD
dor”, declaró Peralta al precisar que el tabasqueño cuenta con el apoyo de diversos sectores para lograrlo.
Por su parte, el diputado federal Óscar Cantón Zetina externó su respaldo a Adán Augusto para que sea candidato presidencial por Morena, porque, dijo, “siem pre apoyaré a un tabasqueño y porque López Hernández está muy identificado con la ideolo
Pide Rutilio Escandón extremar precauciones ante bajas temperaturas y lluvias por frentes
COMUNICADOEL SIE7E
Tuxtla.- Durante la Mesa de Coordinación Estatal para la Cons trucción de la Paz y la Seguridad, el goberna dor Rutilio Escandón Cadenas informó que la llegada de frentes fríos, en las últimas ho ras ha provocado bajas temperaturas y lluvias en Chiapas, sobre todo en municipios de las regiones Norte, Mezca lapa y Soconusco, por lo que exhortó a la po blación a atender medidas preventivas de protección civil y extremar precauciones al viajar por las carreteras ante el riesgo de deslaves de las montañas.
“Las lluvias no son tan intensas, pero la tierra de las montañas ya está mojada debido a las pasadas precipitaciones plu viales. Si no hay necesidad de salir, no lo hagas para evitar algún tipo de accidente a causa de estos fenómenos meteoroló gicos. Cuidemos nuestro patrimonio, la integridad y la vida”.
Asimismo, el mandatario precisó que está por iniciar la temporada invernal, que trae
como consecuencia el aumento de en fermedades respiratorias, entre éstas la influenza, por lo que insistió en el llama do a las chiapanecas y los chiapanecos a vacunarse para proteger la salud y la vida contra este padecimiento.
“Tenemos suficientes biológicos contra la influenza, así que no lo dejemos para mañana; acude a los hospitales, las clí nicas y centros de salud, tanto en las zo nas urbanas como rurales, a fin de que el personal de salud te informe sobre los riesgos de este virus y te aplique la dosis correspondiente”, apuntó.

gía política del presidente de la República, Andrés Manuel López Obrador”, sostuvo. El alcalde de Jonuta, Eric Garri do, aseguró que Adán Augusto será el segundo tabasqueño en ser presidente de México y con eso, dijo, continuará la política de justicia social y las buenas noticias para el sur del país que durante muchos años se mantu vo en el olvido.
De acuerdo con analistas po líticos, Adán Augusto es un hombre auténtico que conoce la problemática social del país, además ha sabido conciliar con los actores de la política, con los sectores sociales, empre sariales, religiosos, colectivos y asociaciones civiles.
En otro orden de ideas, Adán Augusto, quien ha recorrido más de 28 entidades del país para dar a conocer la reforma constitucional en materia de seguridad, ha elevado su posi cionamieno en las preferencias electorales entre morenistas, por arriba del canciller Marcelo Ebrard, según la encuesta de “México Elige”.
Aunado a ello, en su gira nacio nal, el titular de Segob ha sido recibido con porras, música, al garabía, lonas, espectaculares, y con el grito de ¡Presidente! ¡Presidente!, en Jalisco, Oaxa ca, Veracruz, Tamaulipas, Nue vo León, Chihuahua, entre otros estados de la República.
DIRIGENTE ESTATAL
Carlos Molina convoca a la unidad de Morena rumbo a 2024
COMUNICADO - EL SIE7E
Tuxtla.-. El dirigente estatal de Mo rena en Chiapas, Carlos Molina Ve lasco, pidió a las y los simpatizantes del Movimiento de Regeneración Na cional a unir fuerzas rumbo al 2024 y combatir el racismo y el clasismo de la derecha conservadora que bajo engaños pretende mantener sus pri vilegios, calumniando las acciones de la Cuarta Transformación.
Dijo que es momento de demostrar el apoyo hacia el presidente de Mé xico Andrés Manuel López Obrador, y convocó a los legis ladores locales, fede rales, senadores, mili tantes y pueblo sabio de Chiapas a reunirse el próximo 27 de no viembre en el zócalo capitalino para corear en unísono: AMLO no estás solo.
Aseguró que en la próxima reunión de apoyo hacia el Presi dente de México se volverá a sentir todo
el cariño y la confianza de las y los mexicanos, tal y como se hizo el pa sado 1 de julio de 2018 cuando se ganó en un ejército inédito la Presi dencia de la República.
En el caso de Chiapas adelantó que ya se están organizando en los 124 municipios para asistir al encuentro, donde en cada rincón de la entidad se vive un ánimo efervescencia y re gocijo y respaldo Al mandatario. “los que se quieran sumar son bienveni dos, a diferencia de otros grupos po liticos, nosotros estamos en el lado correcto de la historia”, concluyó.

22 DE NOVIEMBRE DE 2022 SIE7E DE CHIAPAS 27 ESTATAL
Descubren que la lepra tiene el potencial de regenerar hígados en animales
miento y la proliferación celular se activaron y los relacionados con el envejecimiento se desregularon, o se suprimieron.
Los científicos creen que se debe a que las bacterias reprogramaron las células del hígado, devolviéndolas a la etapa anterior de células proge nitoras, que a su vez se convirtieron
en nuevos hepatocitos y crearon nuevos tejidos hepáticos.
El equipo confía en que este descu brimiento pueda ayudar a desarro llar intervenciones para el envejeci miento y el daño del hígado en los seres humanos.
“Si logramos identificar cómo las bacterias hacen crecer el hígado



como órgano funcional sin causar efectos adversos en animales vivos, quizá podamos trasladar ese cono cimiento para desarrollar interven ciones terapéuticas más seguras para rejuvenecer hígados enveje cidos y regenerar tejidos dañados”, destacó el autor principal del estu dio Anura Rambukkana.
AGENCIA ID - EL SIE7E
La bacteria que causa la lepra, una de las enfermeda des más antiguas, pueden tener la capacidad de hacer crecer y regenerar el hígado, señala un estudio reali zado con armadillos. Un equipo encabezado de la Uni versidad de Edimburgo, Reino Unido, descubrió que los parásitos asociados a la lepra pueden reprogramar cé lulas para aumentar el tamaño del hígado en animales adultos sin causar daños, cicatrices o tumores, según publica Cell Reports Medicine.
Estudios anteriores promovieron el recrecimiento de hí gados de ratón mediante la generación de células ma dre y progenitoras a través de una técnica invasiva que a menudo provocaba cicatrices y crecimiento de tumo res, recordó la universidad.
Para superar estos efectos secundarios, los investiga dores se basaron en su anterior descubrimiento de la capacidad de reprogramación celular parcial de la bac teria causante de la lepra, Mycobacterium leprae. El equipo infectó a 57 armadillos, que son huéspedes naturales de la bacteria de la lepra, y comparó sus hí gados con el de ejemplares no infectados y otros resis tentes a la infección. Los animales infectados desarro llaron hígados agrandados, aunque sanos e ilesos con los mismos componentes vitales. El equipo cree que las bacterias “secuestraron” la capacidad regenerativa in herente al hígado para aumentar su tamaño y dotarlo de más células con las que aumentar.
Además, descubrieron varios indicadores de que los principales tipos de células hepáticas, los hepatocitos, habían alcanzado un estado “rejuvenecido” en los ar madillos infectados. Esos hígados también contenían patrones de expresión génica (el plano para construir una célula) similares a los de los animales más jóvenes. Los genes relacionados con el metabolismo, el creci
22 DE NOVIEMBRE DE 2022 SIE7E DE CHIAPAS 28 28 ESTATAL REINO
UNIDO
INTERÉS GENERAL
Última hora

Según el Centro Nacional de Donación de Embriones (NEDC, en inglés), aunque no hay datos oficiales globales que lo sustenten, estos embriones serían los más antiguos usados de forma exitosa.
Nacen en EU unos gemelos de embriones congelados hace 30 años
EFE - EL SIE7E
Washington.- Una pareja estadounidense dio a luz hace tres semanas a dos bebés gemelos concebidos hace treinta años, cuyos embriones estaban conge lados desde 1992, informa ron este lunes medios de comunicación estadouni denses.
Según el Centro Nacional de Donación de Embriones (NEDC, en inglés), aun que no hay datos oficiales globales que lo sustenten, estos embriones serían los más antiguos usados de forma exitosa.
La madre es Rachel Ri dgeway y solo tiene tres años más que los embrio nes, que ahora son dos be bés llamados Lydia Ann y
Timothy Ronald. La madre biológica de los bebés era una donante de óvulos de 34 años y su pa dre tenía 50 años cuando fueron concebidos. Según explica la clínica, otros embriones que serían her manos de los actuales pre suntamente fueron implan tados en algún momento en la mujer.
Timothy y Lydia pasaron 15 años esperando en una clí nica de fertilidad de la costa oeste, luego otros 15 alma cenados en el laboratorio de Southeastern Fertility, una clínica médica asocia da a la NEDC. Anteriormen te, un embrión de 24 años y otro de 27 eran los más antiguos empleados de ma nera exitosa en el pasado, a través de NEDC.
¿ EL FIN DEL MUNDO?
Científicos se mantienen en alerta por una señal preocupante en el Polo Sur
AGENCIA ID - EL SIE7E
Científicos de la Universidad de Insubria, en Italia, se mantienen en alerta por una señal preocupante en el Polo Sur, un mensaje que está dando la naturaleza que puede significar que se avecina el fin dle mundo.
De acuerdo con lo citado en el informe publicado en el sitio web de Semana, los expertos detectaron cambios en la flora y fauna de esa zona de la Tierra, producto del aumento de la temperatura.
El Polo Sur es uno de los lugares menos explorados de nuestro planeta, precisa mente la razón por la que la comunidad científica sigue de cerca lo que ocurre allí, especialmente por las temperaturas y el aspecto físico de la Antártida, obje tos de estudio para entender los efectos del cambio climático. La principal preo cupación de los especialistas se debe a que, desde hace 50 años, han estudiado a dos de las pocas plantas que crecen en la referida zona del mundo y que, en los últimos meses, vieron que su expansión se aceleró. Son llamadas la Deschampsia antarctica y el Colobanthus quitensis.
SU FLORECIMIENTO
NO ES DE BUEN AUGURIO Si bien puede parecer que el hecho de
que estas plantas crezcan, su crecimien to parece más rápido que en las últimas décadas, lo que significa que la tempe ratura en esta área empieza a aumentar rápidamente, específicamente en la isla Signy.
Los científicos aseguran que el planeta está llegando a un punto de inflexión del cual no podrá pasar y que el calentamien to global nos llevará al fin del mundo.
Otro de los motivos de la expansión de las plantas tiene que ver con la desapa rición de los lobos marinos, que, produc to de la caza indiscriminada y el mismo cambio climático, son ahora una especie en vía de extinción.
Los expertos concluyen que si el pai saje antártico y la biodiversidad siguen cambiando tan rápidamente, deberemos aceptar esta alerta que el fin del mundo tal y como lo conocemos se acerca.

DESCANSE
EN PAZ
Muere el cantautor cubano Pablo Milanés

EFE - EL SIE7E
La Habana.- El cantautor cubano Pa blo Milanés murió en la noche de este lunes, a los 77 años, tras permanecer ingresado en Madrid durante más de una semana, informaron medios ofi ciales.
Milanés, una de las voces más reco nocidas de la música cubana, fue el fundador y artífice del sonido de la Nueva Trova junto a otros reconoci dos artistas como Silvio Rodríguez y Noel Nicola.
Autor de clásicos como “Yolanda”, Milanés publicó más de 40 discos a lo largo de su carrera y obtuvo, entre otros, el Premio Nacional de Música de Cuba y el Grammy Latino a la Ex celencia Musical.
El cantautor cubano fue hospitalizado el 12 de noviembre en Madrid por “los efectos de una serie de infecciones recurrentes que en los últimos tres meses han venido afectando a su es tado de salud”, según un comunicado de entonces de su oficina artística.
A partir de ese momento suspendió varias actuaciones que tenía previs

tas en Pamplona (España), Ciudad de México y Santo Domingo.
“Esta situación clínica -añadía la nota- es secundaria a una enferme dad oncohematológica que sufre des de hace varios años y que le exigió instalarse en Madrid” a finales de 2017 para recibir tratamiento.
El comunicado explicaba que “de mo mento ha sido necesario cancelar los conciertos previstos en las próximas semanas y suspender toda su activi dad artística mientras dure esta cir cunstancia”.
Pablo Milanés también tuvo que can celar en septiembre un concierto. Una de sus últimas actuaciones en directo fue en junio pasado en La Habana.
22 DE NOVIEMBRE DE 2022 SIE7E DE CHIAPAS 29 ESTATAL
ÚLTIMA HORA
Última hora
La frontera sur de México espera más migrantes tras fin del Título 42 de EU
EFE - EL SIE7E
Tapachula.- El próximo fin del Título 42 en Estados Unidos podría incentivar el flujo migratorio a la frontera sur de México, donde acti vistas y migrantes esperan un incremento de llegadas a la ciudad de Tapachula, en el límite con Guatemala. Migrantes de Venezuela, Ecuador, El Salvador, Co lombia y República Domi nicana que están varados en el sur de México dijeron a EFE tener esperanza una semana des pués de que un juez estadounidense blo queó el Titulo 42, que permite a EE.UU. deportar de forma inmediata a indocu mentados en la frontera.
Al respecto, Luis Rey García Villagrán, di rector del Centro de Dignificación Huma na (CDH) en Chiapas, señaló este lunes a EFE que el cambio, que entra en vigor el 21 de diciembre, va a permitir la entrada y las solicitudes de refugio de venezolanos y miles de personas de otras nacionali dades.
“Retirar el Titulo 42 incrementará la mi gración porque hay que recordar que, por una cuestión cultural, migrantes de todas las nacionalidades buscan llegar en di ciembre a la frontera norte, sobre todo la migración mexicana, se ha incrementado demasiado”, expuso.
EL FIN DE UNA ERA
La resolución judicial del martes pasado no solo tumba una de las últimas barre ras impuestas por el expresidente Donald Trump (2017-2021) a la inmigración, sino que supone un reto para el Gobierno de Joe Biden en medio de detenciones ré cord de indocumentados en la frontera con México.
Solo en octubre hubo 230.000 arrestos en la frontera con México, con más de 78.400 expulsiones del territorio estadou nidense.
En este contexto, García Villagrán lamen tó que la migración siga siendo una ban dera política entre republicanos y demó cratas en Estados Unidos.
Por ello, llamó “pretexto” y “medida polí tica” al Título 42, que deportaba a los mi grantes con el argumento de la pandemia.
MIGRANTES PIDEN OPORTUNIDAD A EEUU
La mayor expectativa surge entre los ve nezolanos, que desde octubre afrontaban la deportación inmediata por la expansión del Título 42 anunciada por el Departa mento de Seguridad Nacional (DHS, en inglés) para controlar la inmigración de Venezuela.
El migrante sirio-venezolano Bahir Abaid comentó a EFE que Estados Unidos debe darle una oportunidad a los venezolanos que llegan por tierra porque hay muchas personas “que son buenas”.
“Pero lamentablemente como en todas partes, hay venezolanos que han hecho cosas malas en Estados Unidos, pero hay padres con niños pequeños que no los dejan ingresar para poder mejorar su calidad de vida y sus servicios”, comentó. Abaid lleva nueve años viajando desde Siria, Líbano, Brasil, Venezuela, Centro américa y por último este tránsito por Mé xico, donde considera que los residentes ayudan a los extranjeros.
MÁS OLEADAS Y CARAVANAS
Con el bloqueo del Título 42, los migran tes en Tapachula esperan más oleadas de personas superiores a las de meses anteriores.
Tan solo el jueves pasado, 300 migrantes de diversas nacionalidades ingresaron por la frontera sur de manera irregular en una caravana para descansar en Ta pachula y después caminar a Estados Unidos.

En este contingente viaja Sandra Agustín, originaria de Guatemala, quien se sintió motivada para ir a Estados Unidos ante el fin del Título 42, ya que ella y sus dos familiares tienen necesidades y enferme dades.
“Venimos caminando, porque no traemos suficiente dinero, por lo que nos organi zaremos y esperamos que vengan más salir”, señaló.
En este contexto, García Villagrán reiteró su petición al Gobierno de México para instalar un “corredor humanitario” que permita transitar a los migrantes por te rritorio mexicano para que lleguen a su destino.
El activista indicó que ya se observan in crementos en la migración, al señalar que más de 140.000 personas han caminado en el último mes desde Ciudad Hidalgo, Chiapas, hasta San Pedro Tapanatepec, Oaxaca, que se ha convertido “en un te rritorio dramático”.
QATAR
La cerveza no es un problema, el brazalete sí
EFE - EL SIE7E
Doha.- No iba a ser una Copa del Mundo tranquila y ya en el segundo partido hay un incendio. La federación inglesa ha pedido Harry Kane, el capi tán, que no lleve el brazalete arcoiris, que desgrana los problemas de Catar y que va más allá de la prohibición de no beber cerveza en los estadios.
“Nos hemos bebido unas cuantas en el apartamento antes de salir, así que no es un drama”, apunto Steve en los aledaños del Khalifa International Sta dium de Doha, donde la afición iraní era mucho más numerosa que la in glesa.
“Sabíamos que harían lo que que rían”, añade, ante la decisión de la FIFA de prohibir la cerveza en es tadios y alrededores a 48 horas del arranque del Mundial. Un veto que tiene su consecuencia social, con miles de aficionados engañados por la promesa de una relajación del tra tamiento del alcohol en este país, y económica, puesto que la FIFA se puede enfrentara a una ruptura con tractual con Budweiser, la proveedo ra oficial de cerveza que ahora solo podrá suministrar su producto en las ‘fan zones’ y la variedad sin alcohol en los estadios.
“Es un poco desconcertante, pero son sus leyes, es su país. Si lo deciden así, no está mal. Ya bebimos suficien tes anoche”, asegura Ryan.
“La Copa del Mundo va sobre cele brarse en diferentes países y unir cul turas, sabes que tienes que aceptar lo”, matiza, despejando el estigma de que los aficionados ingleses no serían capaces de aguantar la prohibición.

Lo cierto es que la masa más proble mática de la afición inglesa no tiene posibilidad ni de viajar hasta Catar, puesto que aquellos ‘hooligans’ con antecedentes de provocar problemas en estadios deben entregar su pasaporte en comisaría antes del comienzo del torneo.
“Si no hay cerveza, tendre mos que jugar mejor para que se diviertan más”, bro meó en rueda de prensa Aa ron Ramsdale.
El problema es que la prohi
bición de la cerveza ha pasado a un segundo plano. Un par de días antes del debut de Inglaterra, la FIFA deci dió imponer el uso de una serie de brazaletes, que tratan diferentes cau sas, para impedir que cada selección utilizara el suyo propio y cercenar, por lo tanto, la iniciativa “OneLove”, esa que pretende dar luz a la discrimina ción existente en Catar, especialmen te a aquella relacionada con los dere chos LGBT.
Para ello, nueve capitanes de selec ciones europeas vestirían un braza lete multicolor. Incluso estas selec ciones aceptaron posibles sanciones económicas. Hasta que la FIFA fue más allá. De la multa económica pasó a la deportiva. Amenazó a los equipos con mostrar amarilla al capitán nada más arrancar el encuentro. Y las na ciones europeas se echaron para atrás.

“Eso es un gran problema. Creo que deberían hacerlo de todos modos. Llevar el brazalete y aceptar la tar jeta amarilla, ese sería un mensaje poderoso. En el segundo partido que le den el brazalete a otro. Y así todos los partidos. Sería un bonito mensaje, porque tenemos que vivir en un mun do inclusivo”, explica Ryan.
“Definitivamente es una decisión con trovertida”, apunta uno de sus amigos. Las redes se han llenado de peti ciones a Kane para que haga oídos sordos a la petición de la FA de que prescinda de este brazalete. Nada haría más ruido que una imagen del delantero inglés siendo amonestado por llevar un brazalete multicolor en el brazo. Nada haría más daño a la FIFA y a su decisión de conceder un Mundial a un país que no respeta los derechos humanos.
22 DE NOVIEMBRE DE 2022 SIE7E DE CHIAPAS 30 30 ESTATAL ÚLTIMA HORA
La resolución judicial del martes pasado no solo tumba una de las últimas barreras impuestas por el expresidente Donald Trump (2017-2021) a la in migración, sino que supone un reto para el Gobierno de Joe Biden en medio de detenciones récord de indocumentados en la frontera con México.
Selva política Rugidos
*Que sea deducible del ISR, la Compra de Medicamentos, Proponen Diputados
*Podría Prohibirse Regalar a Menores de Edad, Bebidas Azucaradas
El diputado federal Juan Francisco Espinoza Eguía (PRI) infor mó que impulsa una iniciativa para hacer deducibles del Impuesto Sobre la Renta (ISR) la compra de medicamentos contra enfermedades crónico dege nerativas, a fin de proteger la salud y derechos de las personas. En un comunicado, indicó que su propuesta busca reformar el artículo 151 de la Ley del Impuesto Sobre la Renta (ISR).
Espinoza Eguía aseguró que avalar este proyecto de decreto permitirá que las personas físicas deduzcan el ISR en la com pra de medicamentos fuera de hospitales.
Indicó que a la fecha la deducibilidad de los medicamentos sólo procede cuando se encuentran incluidos en facturas de servi cios hospitalarios mientras los comprobantes de farmacias no son válidos.
Espinoza Eguía expuso que si el Estado no está cumpliendo con su responsabilidad de cuidar y atender la salud de los mexicanos, no puede obtener contribuciones que provengan directa o indirectamente de la atención a la salud.
El legislador priista sostuvo que las deducciones personales por gastos médicos y hospitalarios no resultan suficientes ante la situación económica que se vive.
Por ello, subrayó que no basta con que los honorarios del doc tor o del especialista sean deducibles de impuestos, porque una de las mayores cargas económicas es la compra cons tante de medicamentos para atender enfermedades crónico degenerativas.
Explicó que los padecimientos degenerativos son aquellos que van avanzando progresivamente hasta que terminan con la vida de una persona sin que exista alguna cura para dete nerlos.
Especificó que son en total siete de las diez principales causas de muerte en el país, entre ellas, la diabetes, el cáncer y el alzheimer.
La pandemia del Covid-19, dijo, tuvo como efecto indirecto una disminución en los servicios preexistentes de salud y ocasionó en el 2020, el gasto de bolsillo de los hogares se incrementara 40 por ciento y 68 por ciento en el concepto de pago por me dicamentos.
Refirió que según cifras del Instituto Nacional de Estadística y Geografía (Inegi), en México hay 12 millones de personas que padecen diabetes.
Señaló que a esto se suma que el estimado en el Presupuesto para 2023, desprotege aún más a quienes no tienen seguridad social y a quienes necesitan medicamentos, porque el presu puesto total para este rubro caerá 15 por ciento respecto a lo avalado para 2022.
En ese sentido, el diputado por Nuevo León aseguró que es un compromiso apoyar desde el ámbito legislativo a los millones de mexicanos que sufren en carne propia el estrés y la preocu pación financiera de afrontar una enfermedad difícil y costosa. Por lo anterior, Espinoza Eguía enfatizó que es imperativo que los medicamentos utilizados para enfrentarlas puedan ser de ducibles de impuesto.
En otro tema, el diputado Antonio Ramírez Ramos (PVEM) informó que impulsa una iniciativa para prohibir que en campa ñas publicitarias o eventos públicos se regalen, suministren u ofrezcan a menores de edad bebidas azucaradas y alimentos procesados con alto contenido calórico.
En un comunicado, indicó que su propuesta busca modificar la Ley Federal de Protección al Consumidor, con el objeto de prohibir la promoción y oferta de dichos productos. Ramírez Ramos refirió que, de acuerdo con la Organización Mundial de la Salud (OMS), México está dentro de los 10 paí ses con mayor índice de obesidad infantil por el elevado con sumo de refrescos y comida chatarra.
Señaló que, lamentable, el consumo excesivo de estas bebi das genera diversos padecimientos como obesidad, diabetes, hipertensión, trastornos hormonales y metabólicos desde eda des muy tempranas.
“Es importante resaltar que los niños y adolescentes no tienen la preocupación de profundizar sobre los efectos negativos que estas bebidas generan en su salud a mediano y largo plazo, de ahí que la industria utilice estrategias de publicidad de manera indiscriminada para eventos públicos y la promoción de estos productos”, explicó.
Consideró que, a pesar de que en México contamos con dis posiciones legales en materia de salud para la protección de la niñez y la adolescencia, así como el etiquetado especial en este tipo de productos, dichas leyes son “letra muerta” ya que los menores de edad consumen estos alimentos sin control alguno.
Ramírez Ramos subrayó que el consumo de bebidas azucara das, refrescos y comida chatarra a edades tempranas violenta el derecho a la salud y atenta contra el interés superior de la niñez, por lo que “es urgente implementar medidas encamina das a prohibir que se les regalen u ofrezcan estos alimentos”.
Finalmente, dijo que la iniciativa fue turnada a la Comisión de Economía, Comercio y Competitividad para su discusión y dic tamen.
De salida les informamos que la diputada Karen Castrejón Tru jillo (PVEM), presidenta de la Comisión de Medio Ambiente y Recursos Naturales, informó que impulsa una iniciativa para que las entidades federativas tengan más facultades y obli gaciones de legislar en materia ambiental, particularmente en materia de reciclaje y reutilización de residuos.
En un comunicado, informó que su propuesta plantea modificar el artículo 100 de la Ley General para la Prevención y Gestión Integral de los Residuos, para “evitar que leyes locales sean declaradas inconstitucionales, al ser impugnadas por parte de quienes se oponen a restringir o prohibir el uso de algunos pro ductos que contienen materiales plásticos”.
Refirió que la Suprema Corte de Justicia de la Nación se pro nunció en agosto pasado sobre la inconstitucionalidad del mo delo de reformas legislativas que ha permitido avances signifi cativos en la mayoría de las entidades federativas.
“La controversia surgió debido a que sólo la Federación tiene la facultad de dirigir la política ambiental nacional para definir en las Normas Oficiales Mexicanas los mecanismos de reducción, reciclaje y reutilización de residuos”, comentó.
Por esta razón, dijo, propone establecer que las leyes loca les contengan prohibiciones sobre la entrega de determina dos productos, envases, empaques y embalajes de plástico y poliestireno expandido que al desecharse se convierten en residuos.
Castrejón Trujillo destacó que “gracias a las reformas aproba das en algunas entidades, hoy en día hay restricciones a la en trega de bolsas de plástico, popotes y productos desechables, que han sido bien aceptadas por la ciudadanía y han permitido generar conciencia para transitar hacia modelos de consumo más sostenibles”.
La iniciativa precisa que, “sin perjuicio de que la Federación continúe con la facultad de emitar las normas oficiales, se revi se la legislación nacional y se garantice el derecho a un medio ambiente sano para el desarrollo y bienestar de cualquier per sona, así como el cumplimiento del principio de progresividad de los derechos humanos, en su vertiente de no regresividad, consagrado en el párrafo tercero del artículo 1° de la Consti tución Política”.
Castrejón Trujillo argumentó que la mayor parte de los produc tos elaborados con materiales plásticos concebidos para “usar y desechar”, como bolsas de plástico, popotes, vasos, platos, cubiertos y demás utensilios desechables, terminan en ríos, playas, bosques y mares, en perjuicio del equilibrio del suelo, los ecosistemas marinos y la fauna, con afectaciones a la ca dena trófica, incluso de los seres humanos.
Indicó que en un escenario catastrófico, de acuerdo con el Foro Económico Mundial, “si no se toman decisiones urgentes, en el año 2050 habrá más plástico que peces en el mar”.
Buenos Deseos
La Selección Mexicana de Futbol hace su debut este mar tes en el Mundial de Qatar, al enfrentarse a contraparte de Polonia, juego que paralizará la mayoría de las actividades en nuestro país por espacio de dos horas.
Fiel a sus usos y costumbres, la afición mexicana prenderá veladoras, rezará, se encomendará a todos los santos y pe dirá el milagro de ver ganar al equipo mexicano, el cual, sobra decirlo, no está en su mejor momento.
Los aficionados mexicano que sí creen en su selección, aseguran y confían en que México obtendrá su primer triunfo en la Copa del Mundo; sin embargo aquellos com patriotas que dudan del buen desempeño en el futbol, han adelantado que el juego de este martes será el primero que perderemos.
Cualquiera que sea el resultado, habrá que tener las luces de alerta encendidas, toda vez que conociendo a la afición mexicana, los desmanes por ganar o perder, podrían con cretarse con resultados nada favorables.
EL CARTÓN

La frase del día
Asegura el Secretario de Gobernación, Adán Augusto López que la manifestación del pasado 13 de noviembre realmente no fue una marcha.
22 DE NOVIEMBRE DE 2022 SIE7E DE CHIAPAS 31 ESTATAL
“Caricatura, marcha a favor del INE “
EDITORIAL



MARTES 22 DE NOVIEMBRE DEL 2022 · AÑO 11 · Nº. 4163 · 32 PÁGINAS · VALOR $7.00 WWW.SIE7EDECHIAPAS.COM



















 COMUNICADO - EL SIE7E
COMUNICADO - EL SIE7E










 COMUNICADO - EL SIE7E
COMUNICADO - EL SIE7E


































 AGENCIAS - EL SIE7E
AGENCIAS - EL SIE7E






 ANNETE LEWIS DEPORTE@ SIE7EDECHIAPAS.COM.MX
ANNETE LEWIS DEPORTE@ SIE7EDECHIAPAS.COM.MX









 EFE · EL SIE7E
EFE · EL SIE7E